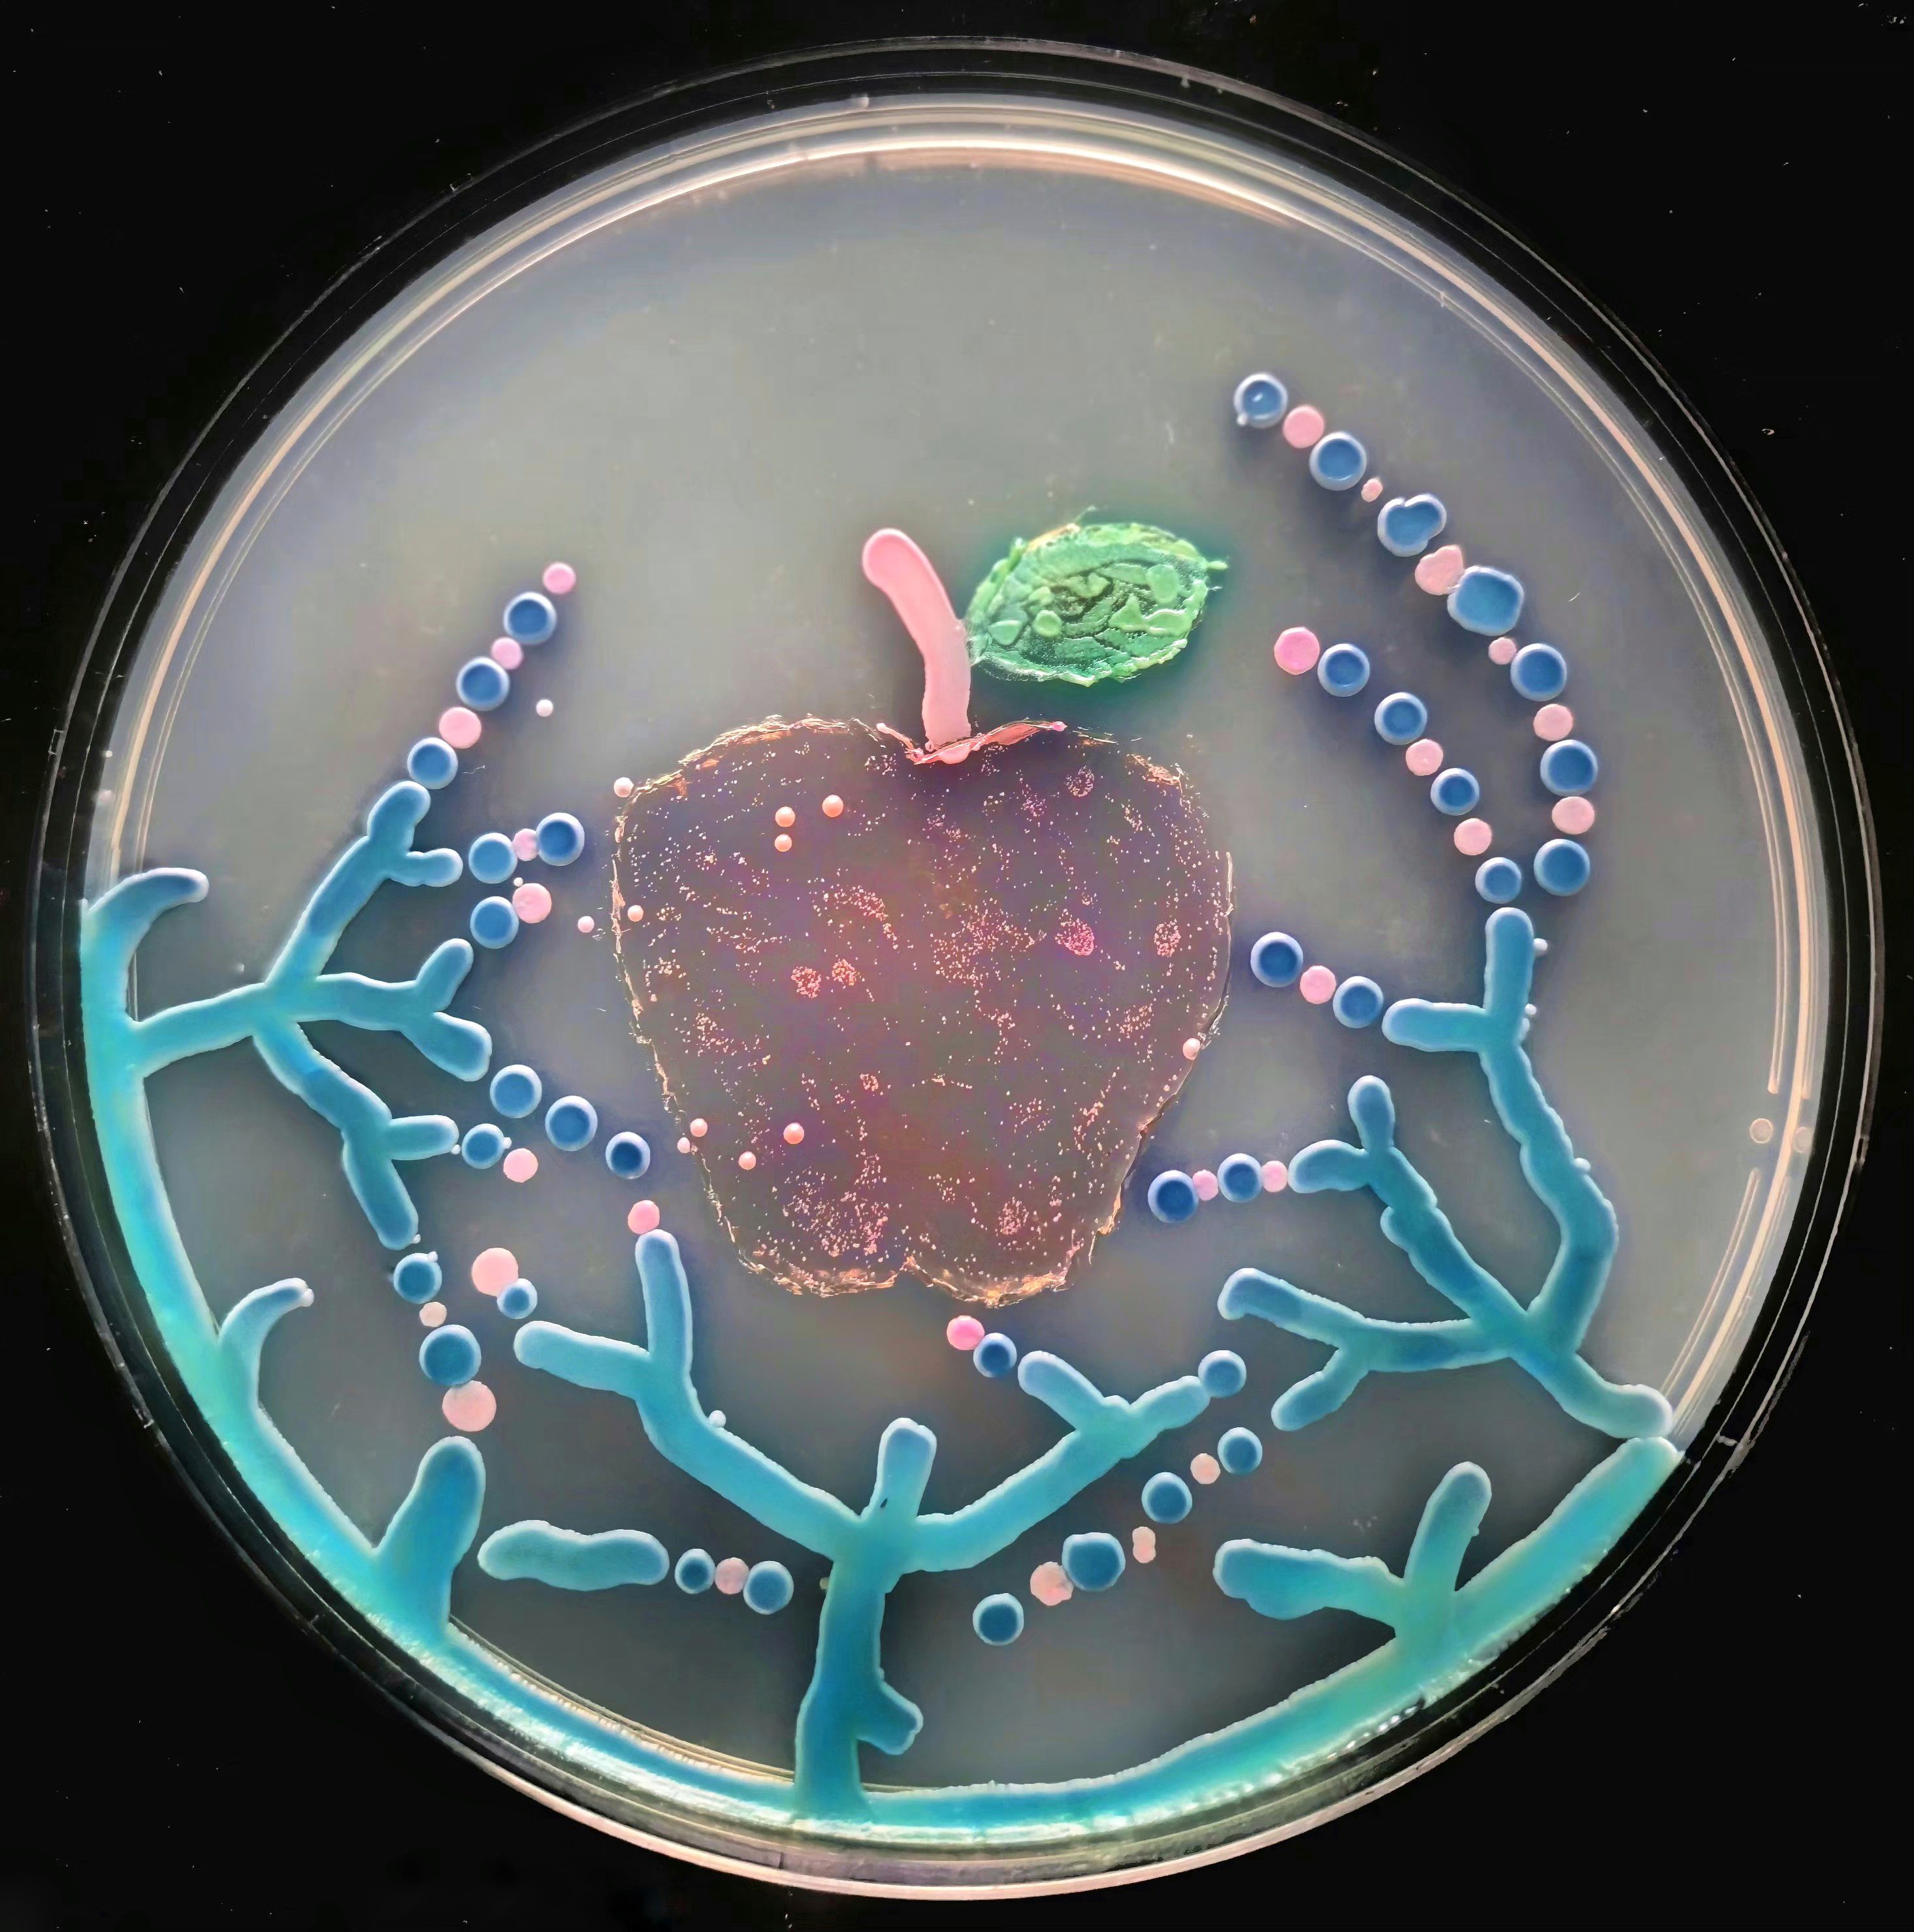
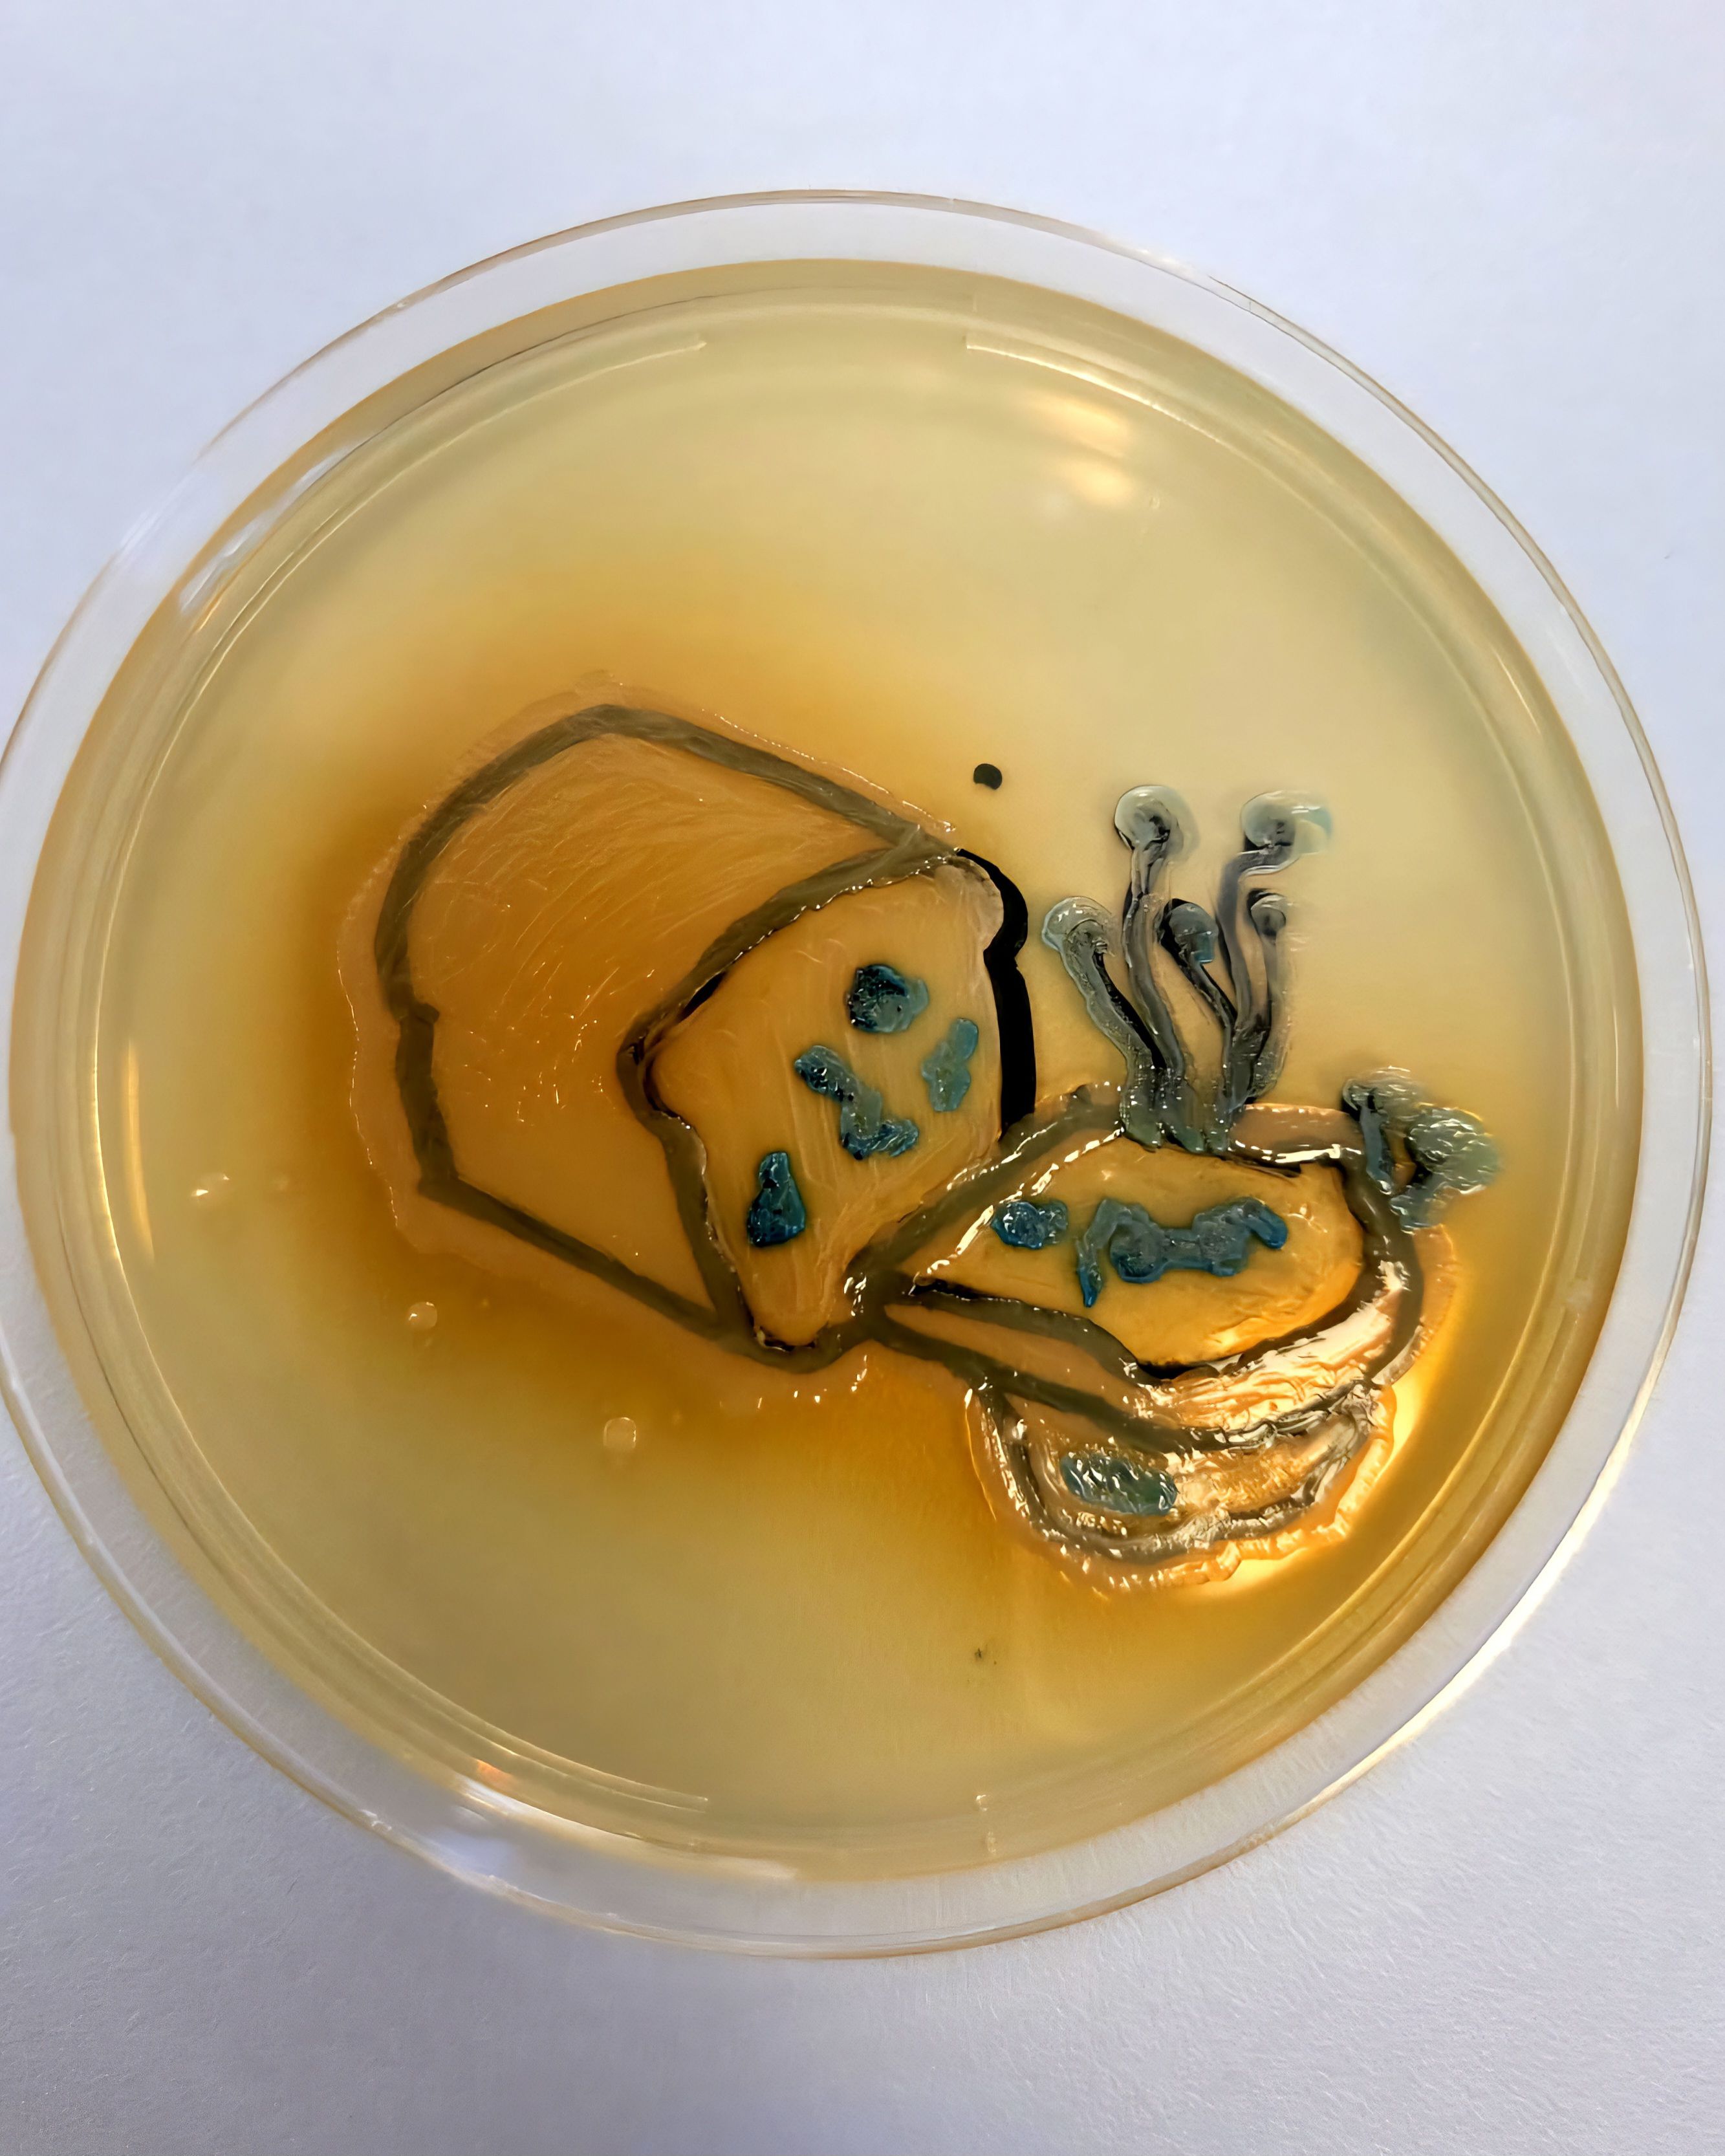
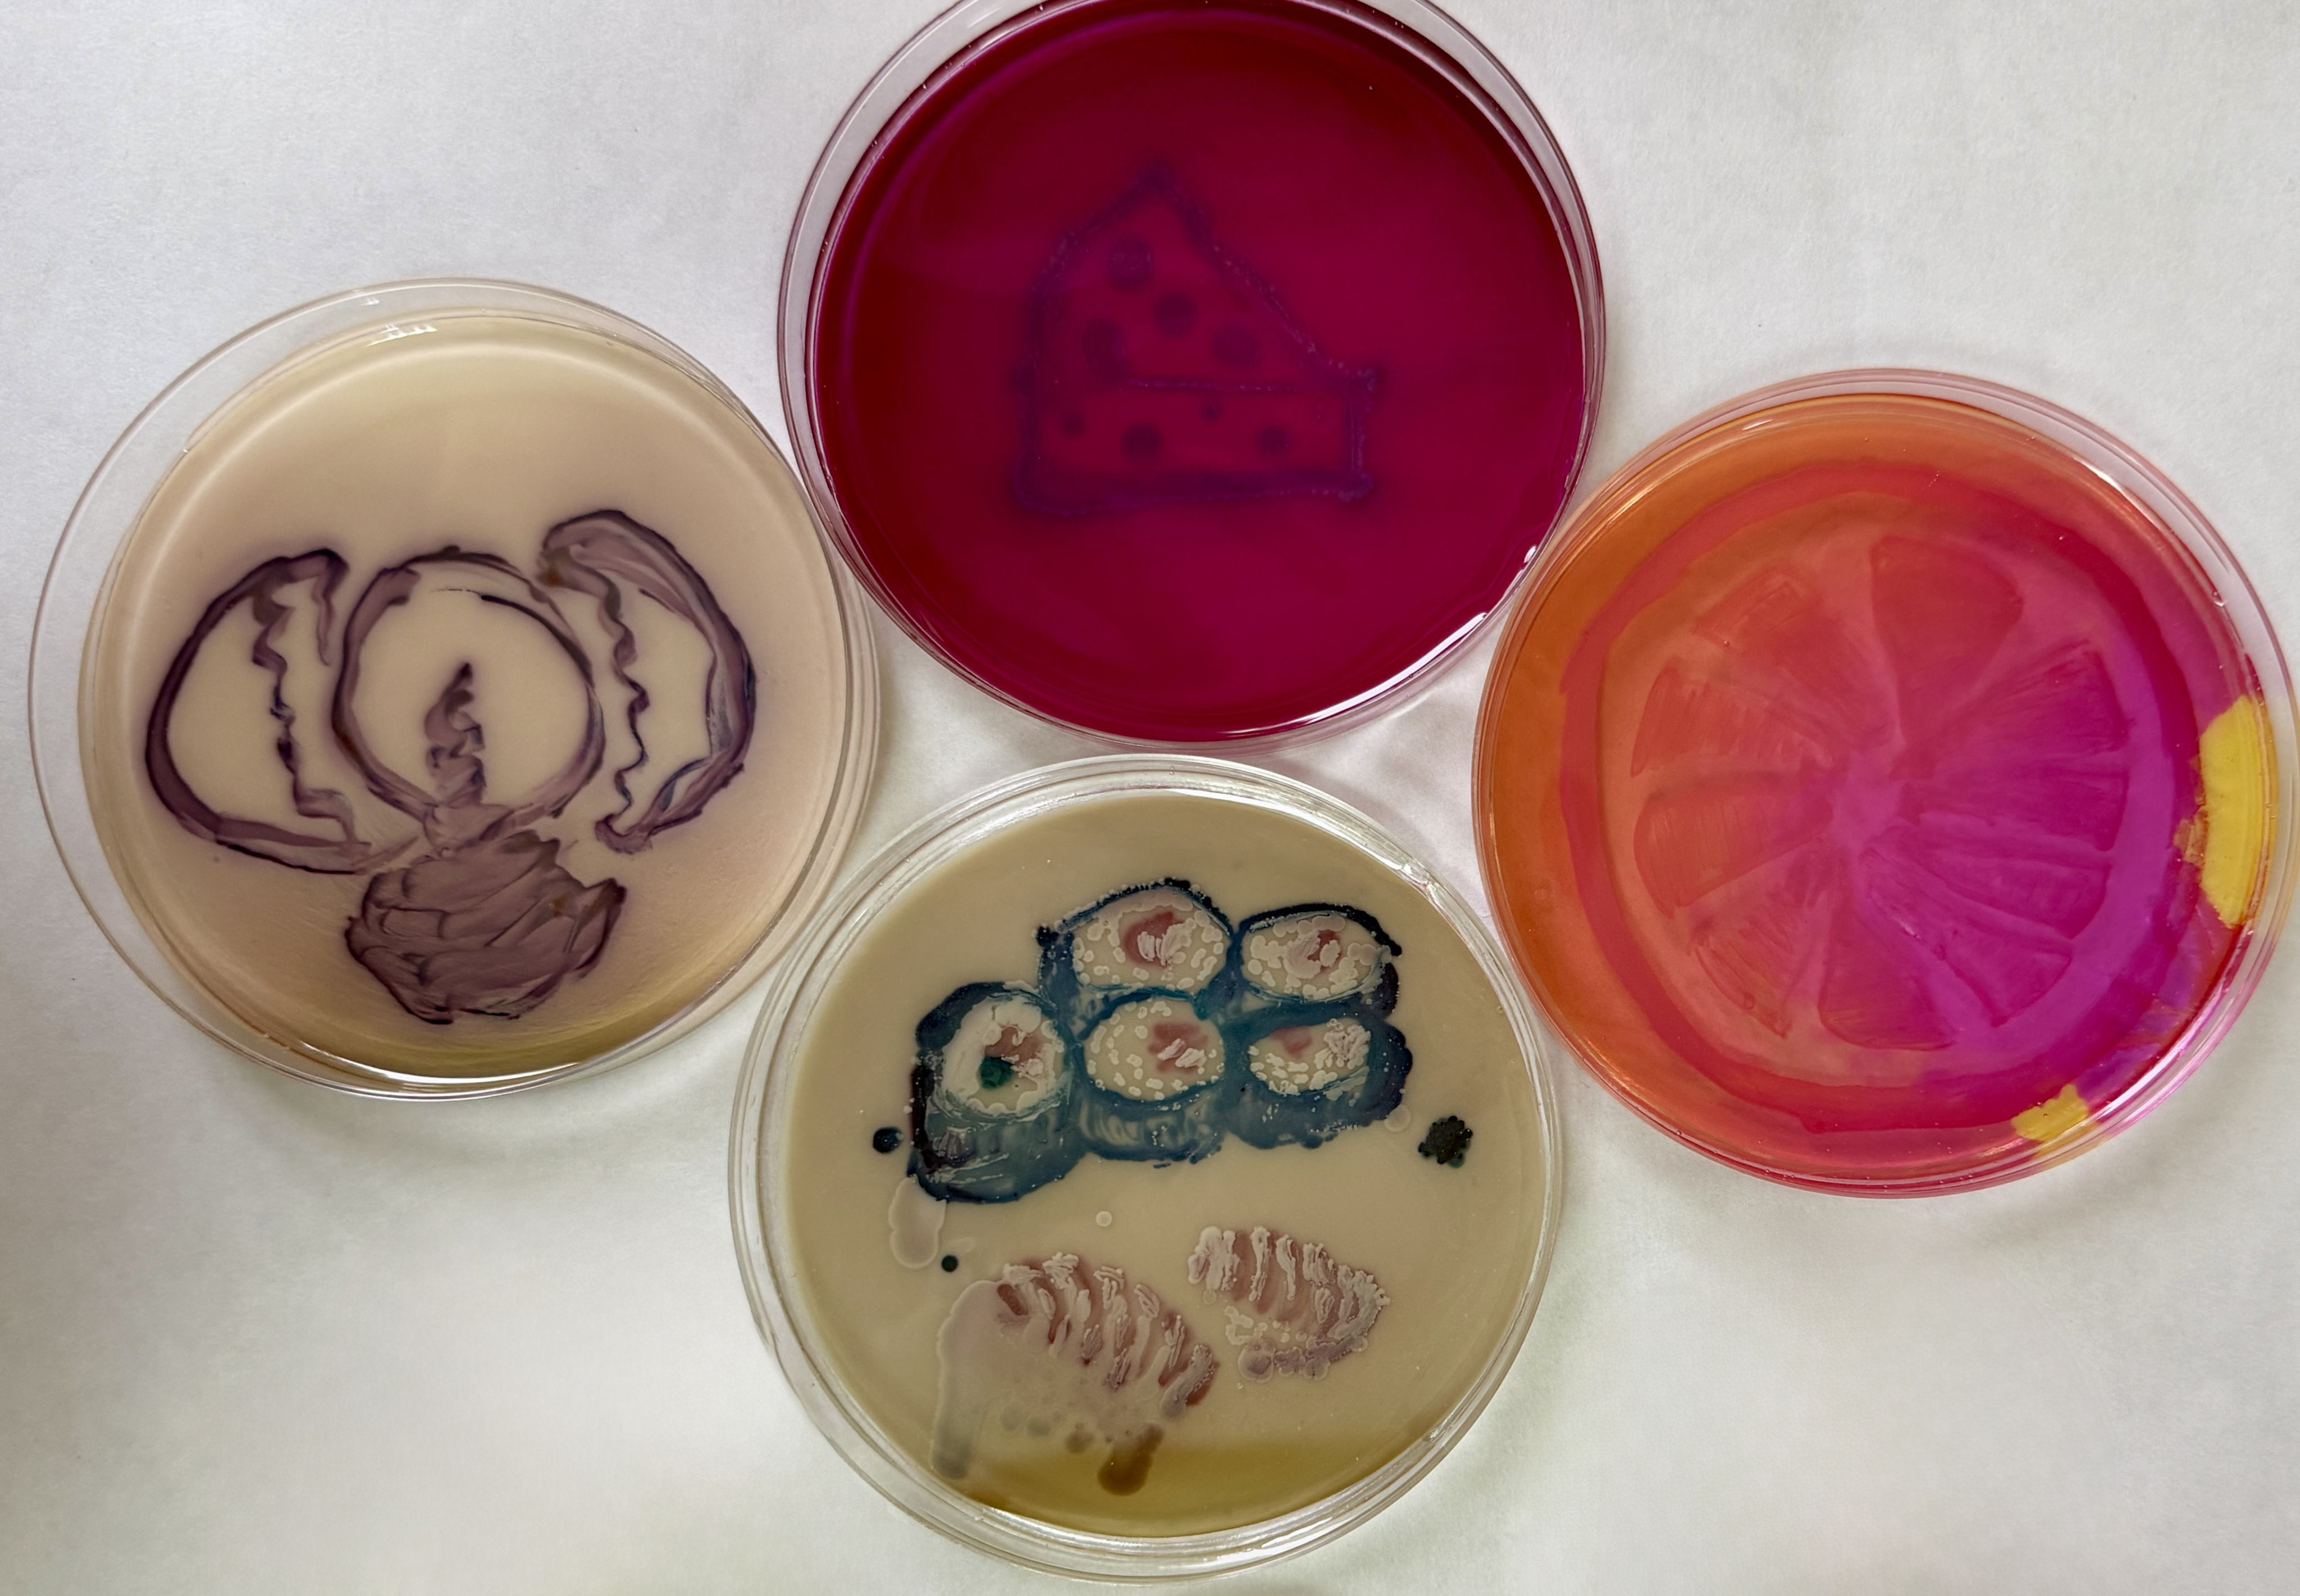
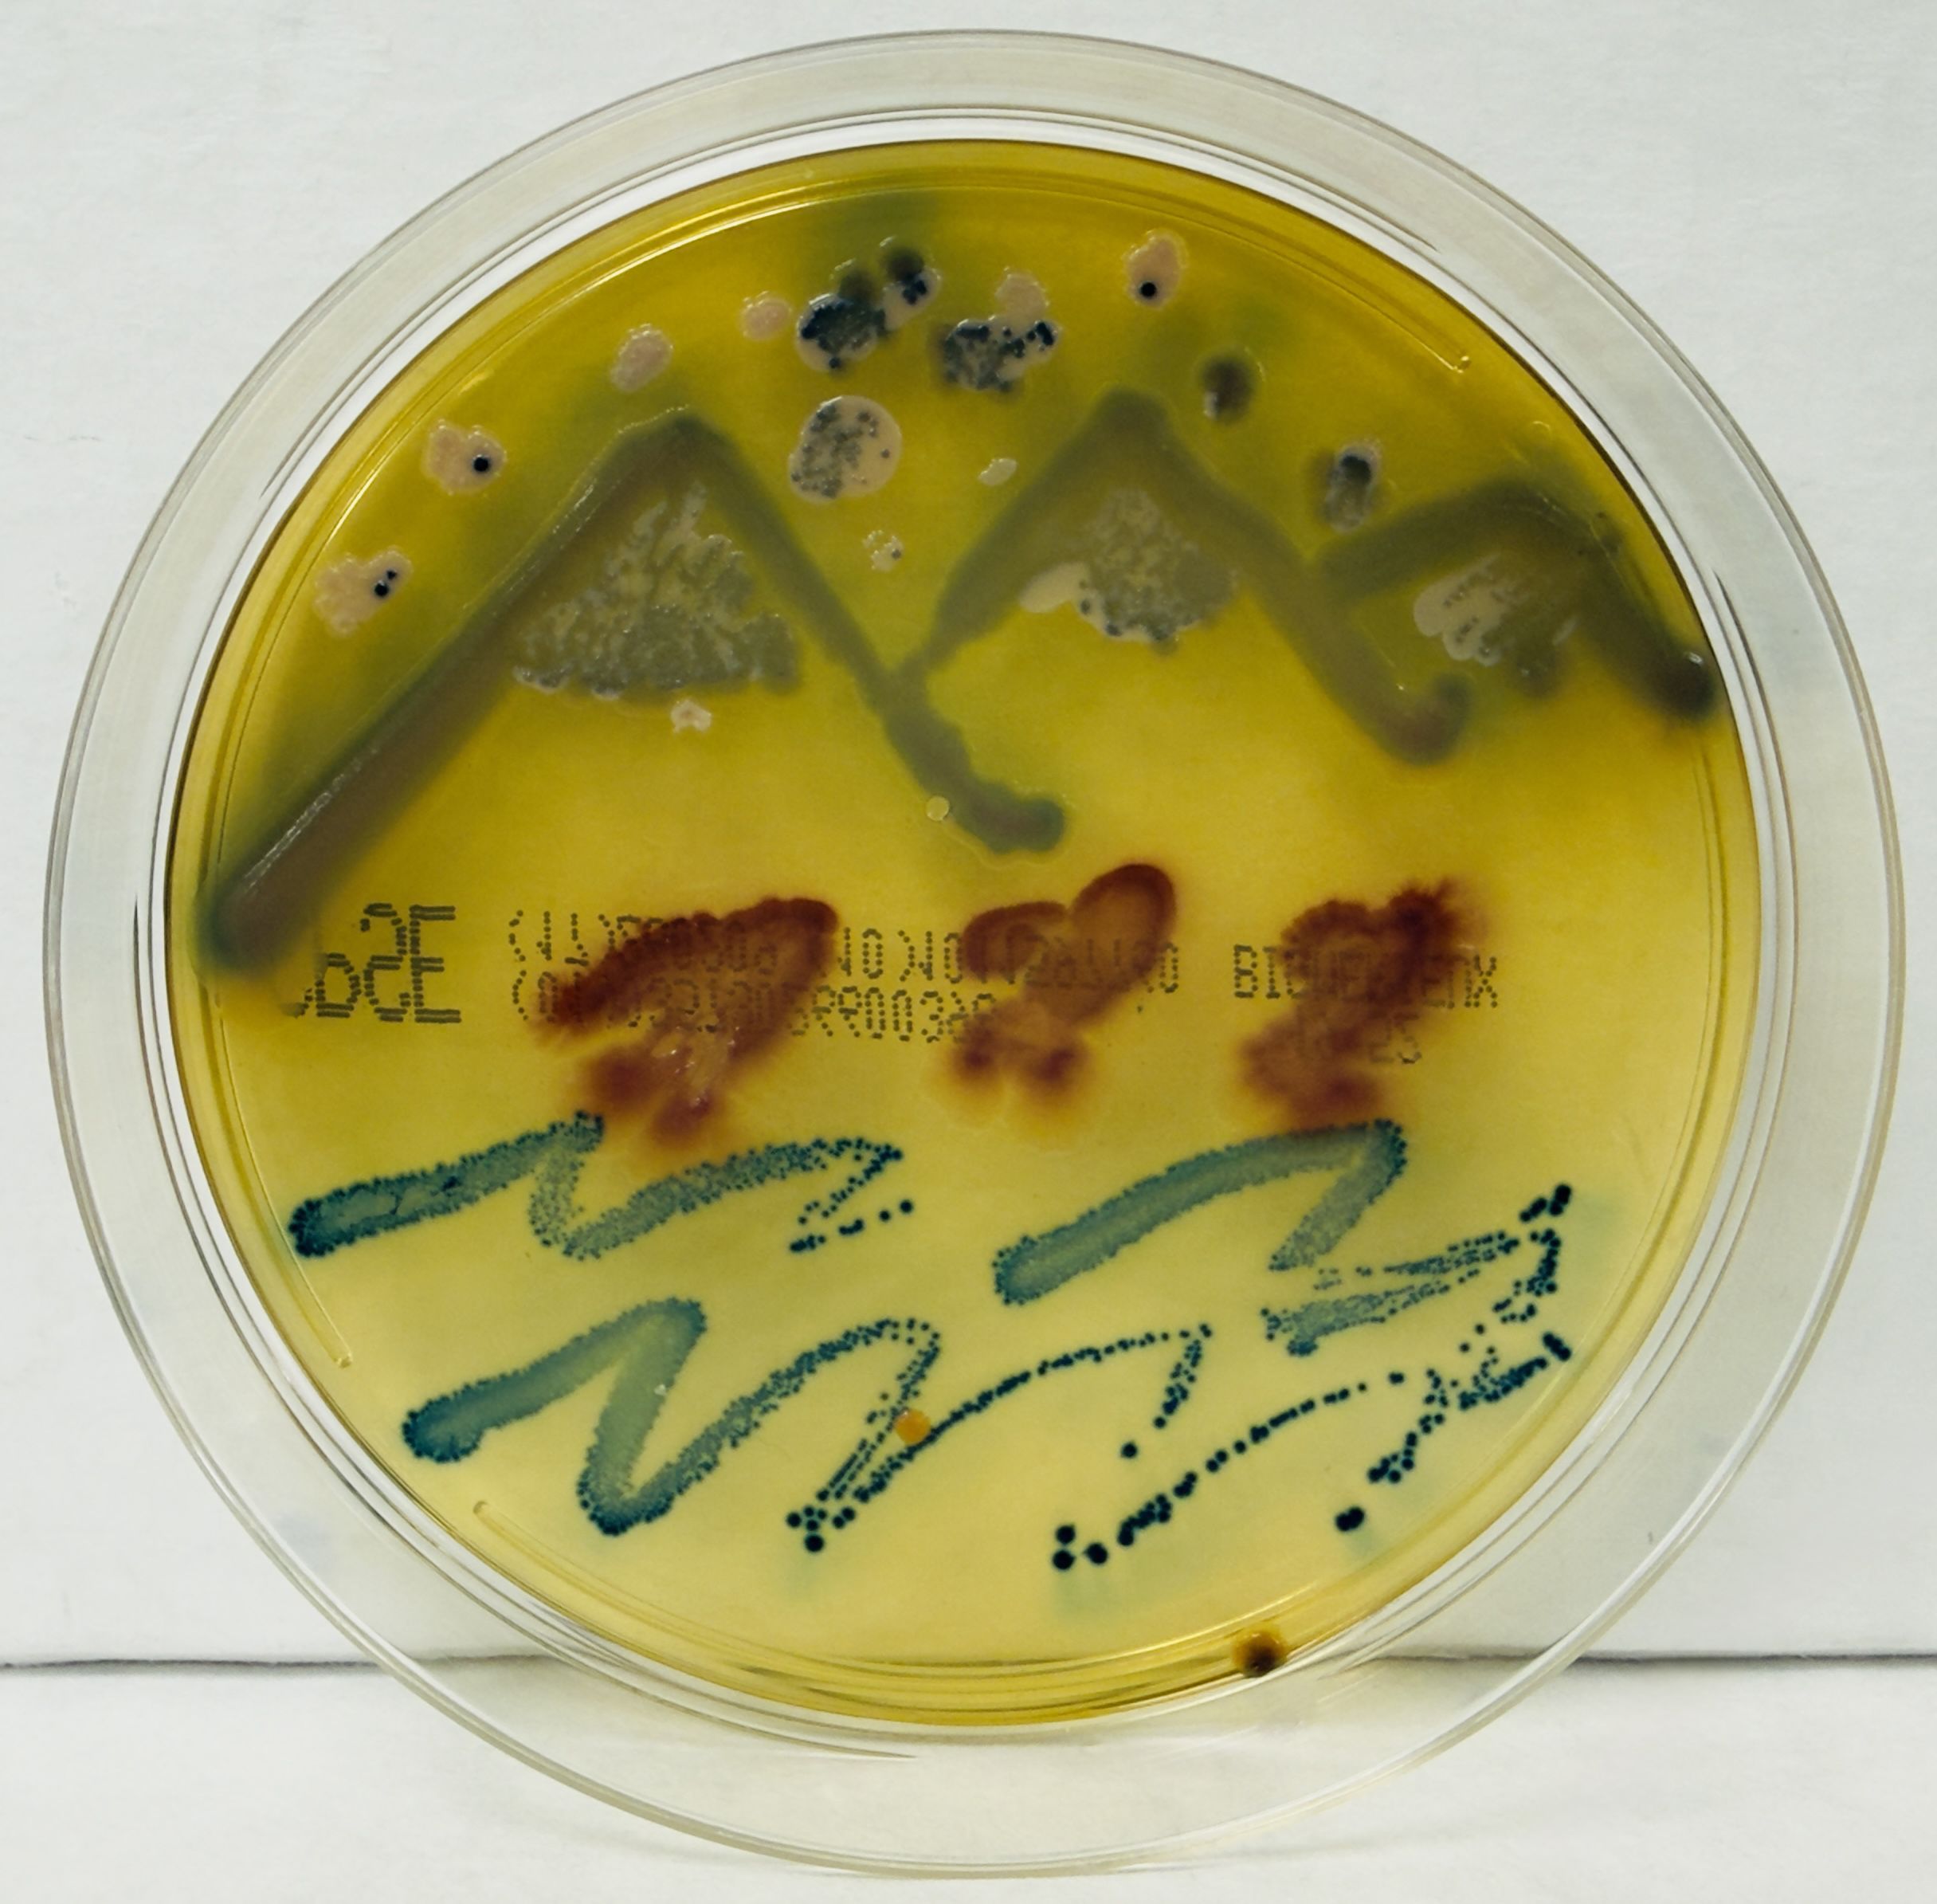
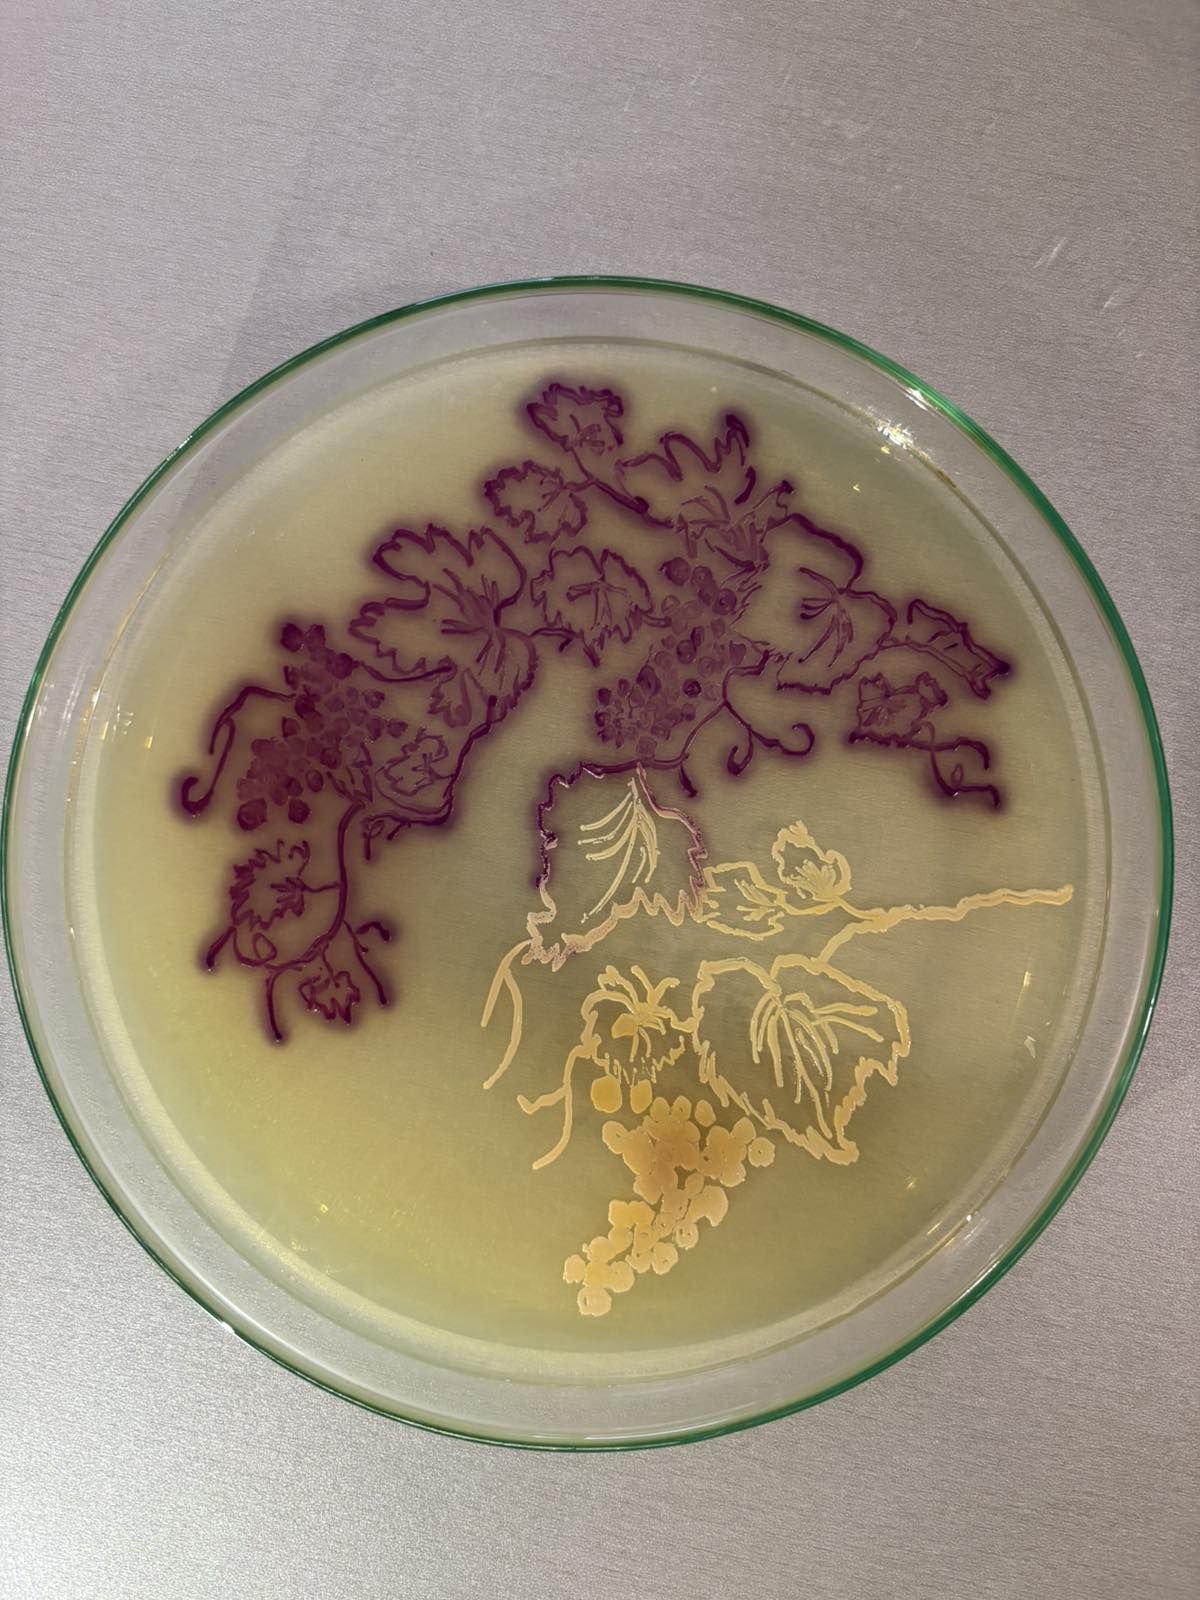
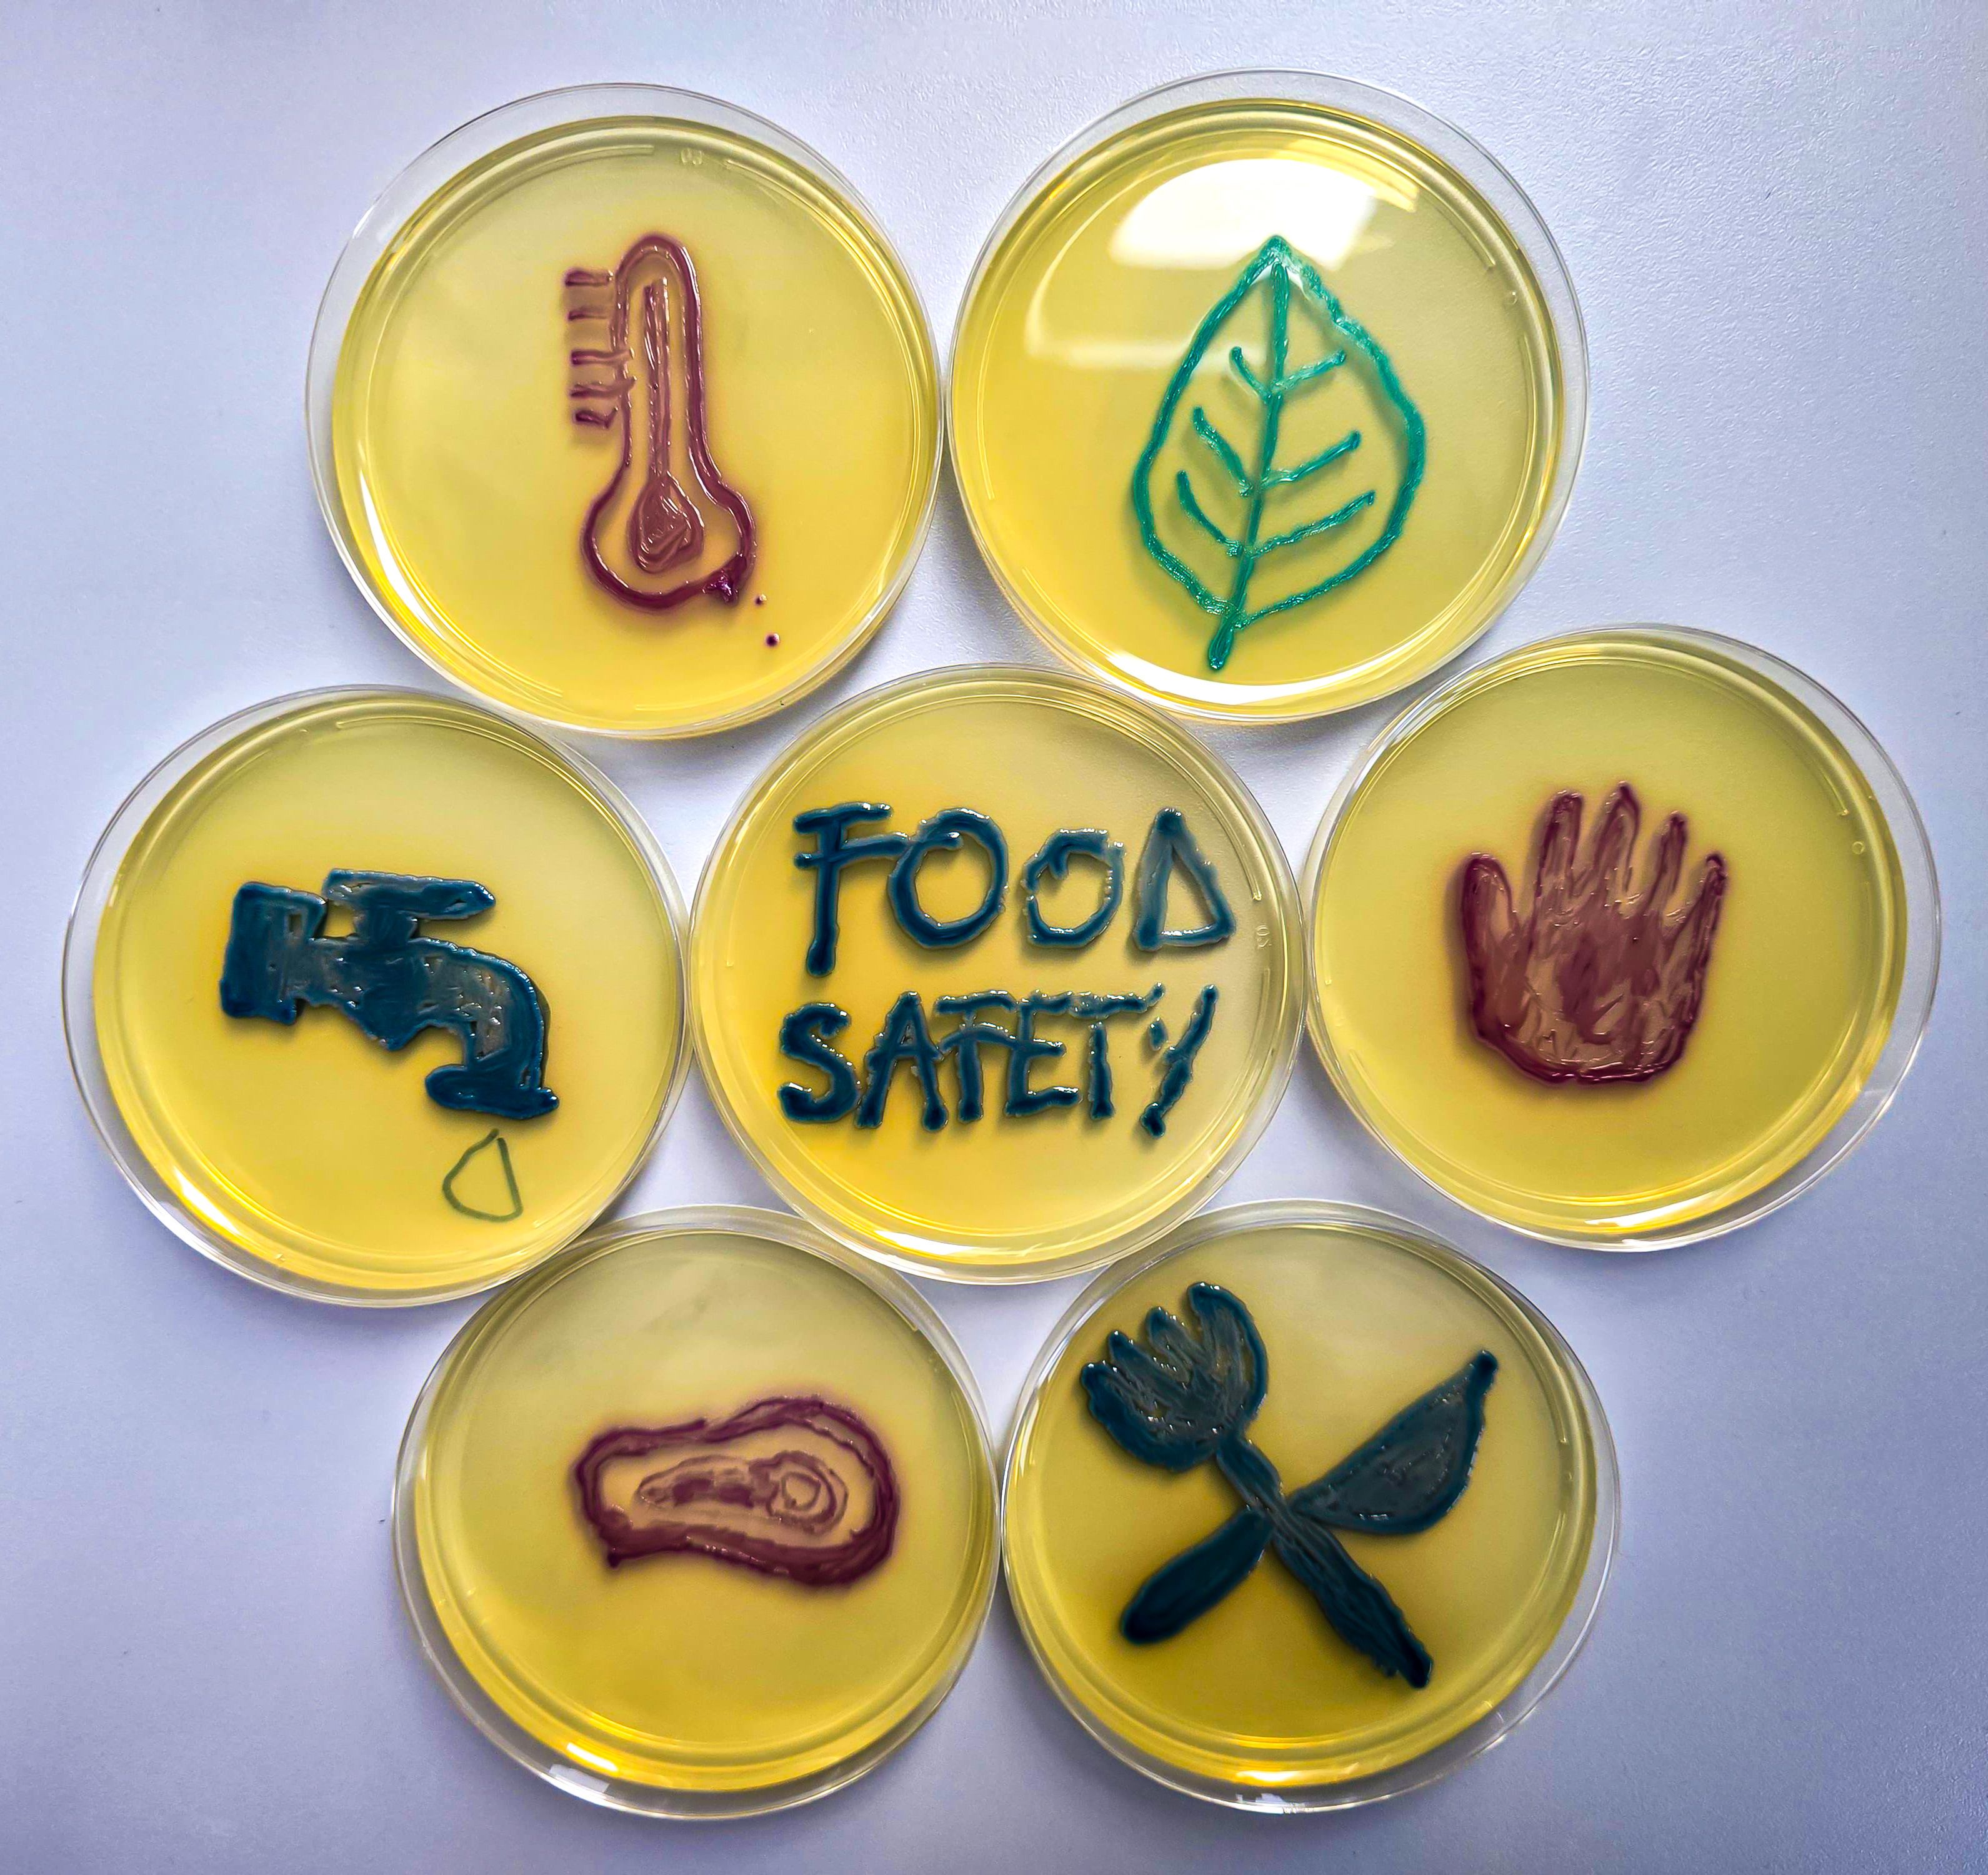
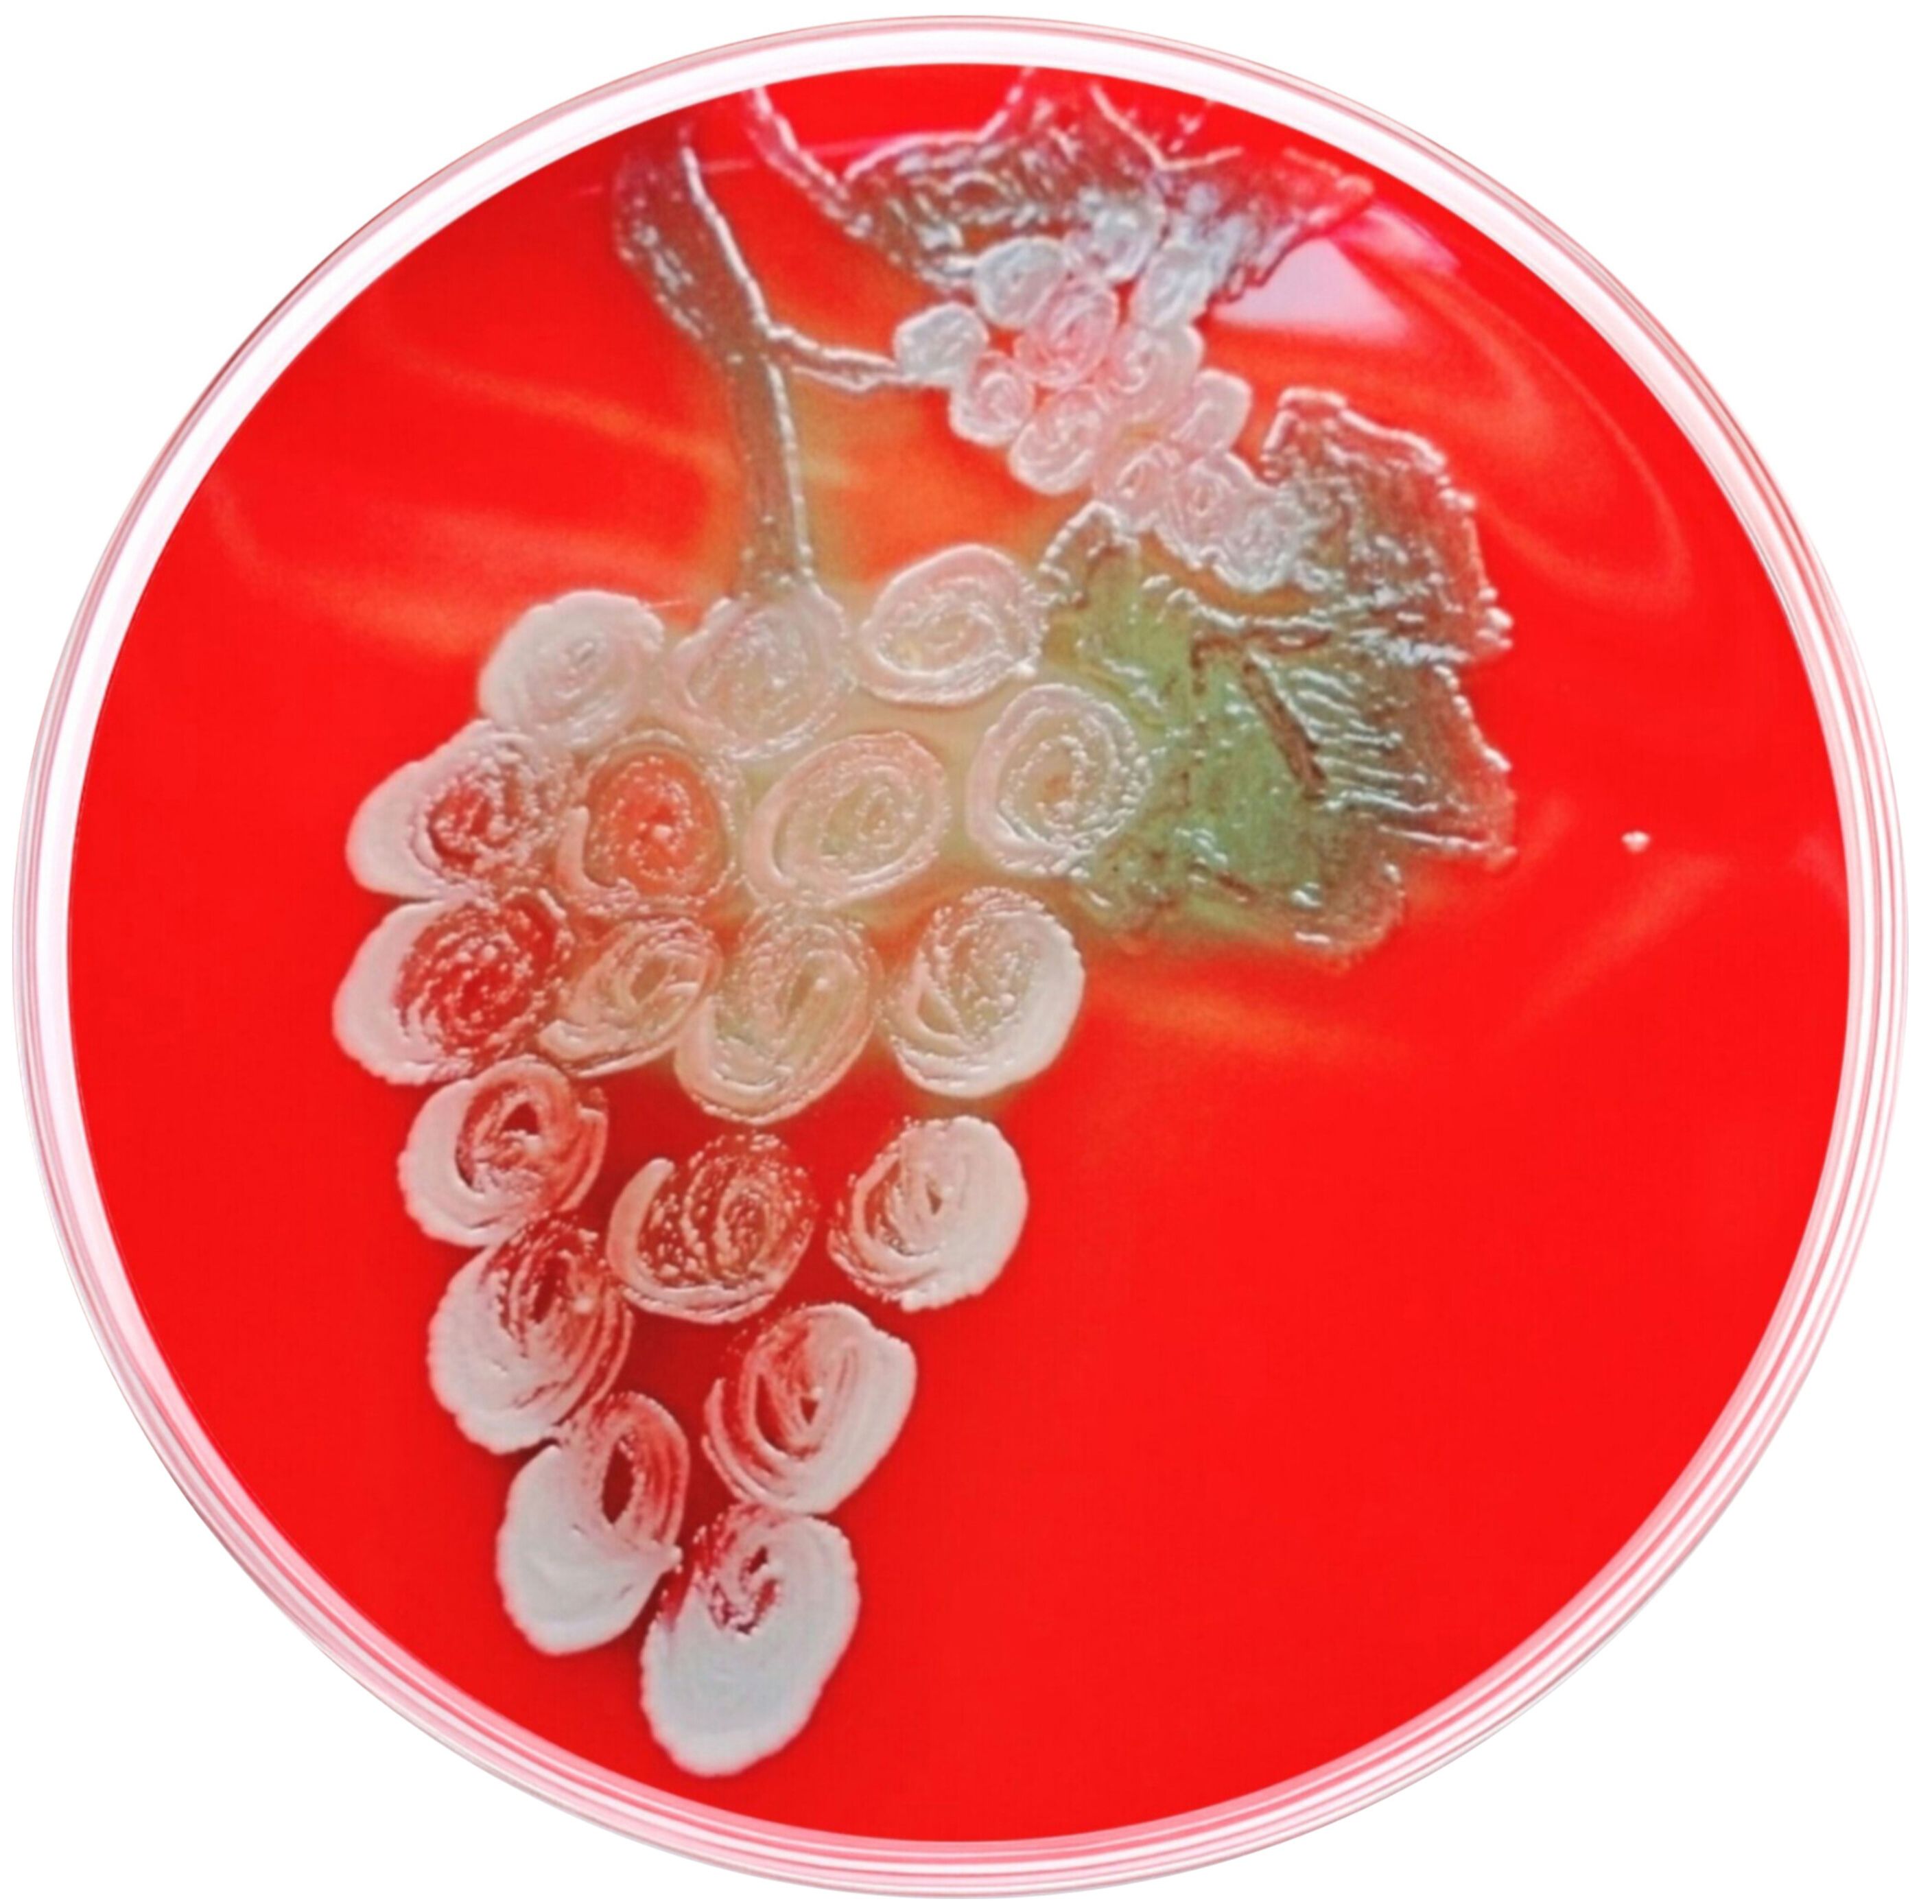

Pathology
Captures
2026
Our annual celebration of #pathart
featuring our favorite artists:
The Pathologist readers!

Welcome to the 11th edition of The Pathologist image feature! Our incredible art galleries are the perfect showcase for the creativity within the pathology community. This year, we’ve been blessed with a plethora of paintings, slide image art, poems, sculptures, and cakes galore! Plus, we’ve partnered with ESCMID Global to showcase “Food Safety” themed artwork across both The Pathologist and ESCMID Global platforms – providing even further reach for your amazing #pathart.
Now, take a step into our gallery to see the beauty that “Pathology Captures”.
Interested in getting your #pathart creations into a future edition of The Pathologist? Share your work with us to feature as our next image of the month!
Painting / Drawing
Microscopic Earth: A Pathologist’s Landscape by Aishwarya Gupta, 3rd year Junior Resident at Hind Institute of Medical Sciences, Barabanki, India. As our professors say, there is a whole new world inside the microscope, so I have depicted how nature and pathology are inseparably linked. This artwork reveals how microscopic patterns mirror the shapes and rhythms of the natural world. Within the microscope’s lens, realistic H&E-stained cells transform into a living landscape like epidermis becomes rolling land, hair follicles rise like climbing vines, rosette formations bloom into flowers, phyllodes patterns unfold into leaves, and actinomycetes radiate like the sun, with more waiting for the eyes to discover. This piece celebrates the beauty of pathology and the universe hidden within every slide and disease.
Microscopic Earth: A Pathologist’s Landscape by Aishwarya Gupta, 3rd year Junior Resident at Hind Institute of Medical Sciences, Barabanki, India. As our professors say, there is a whole new world inside the microscope, so I have depicted how nature and pathology are inseparably linked. This artwork reveals how microscopic patterns mirror the shapes and rhythms of the natural world. Within the microscope’s lens, realistic H&E-stained cells transform into a living landscape like epidermis becomes rolling land, hair follicles rise like climbing vines, rosette formations bloom into flowers, phyllodes patterns unfold into leaves, and actinomycetes radiate like the sun, with more waiting for the eyes to discover. This piece celebrates the beauty of pathology and the universe hidden within every slide and disease.
Caseous Necrosis by Akshi Raj, MD pathology, Assistant Professor at DR. DY Patil Medical College, Hospital and Research Center, Pune Maharashtra, India. A collection of illustrations showing various forms of necrosis.
Caseous Necrosis by Akshi Raj, MD pathology, Assistant Professor at DR. DY Patil Medical College, Hospital and Research Center, Pune Maharashtra, India. A collection of illustrations showing various forms of necrosis.
Coagulative Necrosis by Akshi Raj, MD pathology, Assistant Professor at DR. DY Patil Medical College, Hospital and Research Center, Pune Maharashtra, India. A collection of illustrations showing various forms of necrosis.
Coagulative Necrosis by Akshi Raj, MD pathology, Assistant Professor at DR. DY Patil Medical College, Hospital and Research Center, Pune Maharashtra, India. A collection of illustrations showing various forms of necrosis.
Gangrenous Necrosis by Akshi Raj, MD pathology, Assistant Professor at DR. DY Patil Medical College, Hospital and Research Center, Pune Maharashtra, India. A collection of illustrations showing various forms of necrosis.
Gangrenous Necrosis by Akshi Raj, MD pathology, Assistant Professor at DR. DY Patil Medical College, Hospital and Research Center, Pune Maharashtra, India. A collection of illustrations showing various forms of necrosis.
Liquefactive Necrosis by Akshi Raj, MD pathology, Assistant Professor at DR. DY Patil Medical College, Hospital and Research Center, Pune Maharashtra, India. A collection of illustrations showing various forms of necrosis.
Liquefactive Necrosis by Akshi Raj, MD pathology, Assistant Professor at DR. DY Patil Medical College, Hospital and Research Center, Pune Maharashtra, India. A collection of illustrations showing various forms of necrosis.
Necrosis by Akshi Raj, MD pathology, Assistant Professor at DR. DY Patil Medical College, Hospital and Research Center, Pune Maharashtra, India. A collection of illustrations showing various forms of necrosis.
Necrosis by Akshi Raj, MD pathology, Assistant Professor at DR. DY Patil Medical College, Hospital and Research Center, Pune Maharashtra, India. A collection of illustrations showing various forms of necrosis.
Adenocarcinoma, Pap Smear by Aneta Vareškić, Molecular Biologist (Genetics) at the University Clinical Center Tuzla, Bosnia and Herzegovina and Ivana Čerkez, Pathology Resident at the University Clinical Center Tuzla, Bosnia and Herzegovina.
Adenocarcinoma, Pap Smear by Aneta Vareškić, Molecular Biologist (Genetics) at the University Clinical Center Tuzla, Bosnia and Herzegovina and Ivana Čerkez, Pathology Resident at the University Clinical Center Tuzla, Bosnia and Herzegovina.
Epithelial Tissues by Aneta Vareškić, Molecular Biologist (Genetics) at the University Clinical Center Tuzla, Bosnia and Herzegovina and Ivana Čerkez, Pathology Resident at the University Clinical Center Tuzla, Bosnia and Herzegovina. Inspired by mucinous carcinoma, this piece reflects pathological alterations of epithelial tissues involved in digestion and interaction with dietary components, highlighting how disruption of normal barriers can impact health.
Epithelial Tissues by Aneta Vareškić, Molecular Biologist (Genetics) at the University Clinical Center Tuzla, Bosnia and Herzegovina and Ivana Čerkez, Pathology Resident at the University Clinical Center Tuzla, Bosnia and Herzegovina. Inspired by mucinous carcinoma, this piece reflects pathological alterations of epithelial tissues involved in digestion and interaction with dietary components, highlighting how disruption of normal barriers can impact health.
Gastrointestinal Flowers by Aneta Vareškić, Molecular Biologist (Genetics) at the University Clinical Center Tuzla, Bosnia and Herzegovina and Ivana Čerkez, Pathology Resident at the University Clinical Center Tuzla, Bosnia and Herzegovina. This artwork is inspired by normal colonic histology, emphasizing the organized glandular architecture and epithelial integrity that form the basis of gastrointestinal health and effective interaction with dietary and environmental factors.
Gastrointestinal Flowers by Aneta Vareškić, Molecular Biologist (Genetics) at the University Clinical Center Tuzla, Bosnia and Herzegovina and Ivana Čerkez, Pathology Resident at the University Clinical Center Tuzla, Bosnia and Herzegovina. This artwork is inspired by normal colonic histology, emphasizing the organized glandular architecture and epithelial integrity that form the basis of gastrointestinal health and effective interaction with dietary and environmental factors.
Granulosa Cell Tumor by Aneta Vareškić, Molecular Biologist (Genetics) at the University Clinical Center Tuzla, Bosnia and Herzegovina and Ivana Čerkez, Pathology Resident at the University Clinical Center Tuzla, Bosnia and Herzegovina.
Granulosa Cell Tumor by Aneta Vareškić, Molecular Biologist (Genetics) at the University Clinical Center Tuzla, Bosnia and Herzegovina and Ivana Čerkez, Pathology Resident at the University Clinical Center Tuzla, Bosnia and Herzegovina.
HG SIL, Pap Smear by Aneta Vareškić, Molecular Biologist (Genetics) at the University Clinical Center Tuzla, Bosnia and Herzegovina and Ivana Čerkez, Pathology Resident at the University Clinical Center Tuzla, Bosnia and Herzegovina.
HG SIL, Pap Smear by Aneta Vareškić, Molecular Biologist (Genetics) at the University Clinical Center Tuzla, Bosnia and Herzegovina and Ivana Čerkez, Pathology Resident at the University Clinical Center Tuzla, Bosnia and Herzegovina.
HG SIL, Pap Smear by Aneta Vareškić, Molecular Biologist (Genetics) at the University Clinical Center Tuzla, Bosnia and Herzegovina and Ivana Čerkez, Pathology Resident at the University Clinical Center Tuzla, Bosnia and Herzegovina.
HG SIL, Pap Smear by Aneta Vareškić, Molecular Biologist (Genetics) at the University Clinical Center Tuzla, Bosnia and Herzegovina and Ivana Čerkez, Pathology Resident at the University Clinical Center Tuzla, Bosnia and Herzegovina.
Neuroendocrine Tumor Cytology by Aneta Vareškić, Molecular Biologist (Genetics) at the University Clinical Center Tuzla, Bosnia and Herzegovina and Ivana Čerkez, Pathology Resident at the University Clinical Center Tuzla, Bosnia and Herzegovina.
Neuroendocrine Tumor Cytology by Aneta Vareškić, Molecular Biologist (Genetics) at the University Clinical Center Tuzla, Bosnia and Herzegovina and Ivana Čerkez, Pathology Resident at the University Clinical Center Tuzla, Bosnia and Herzegovina.
Signet Ring Cell Adenocarcinoma by Aneta Vareškić, Molecular Biologist (Genetics) at the University Clinical Center Tuzla, Bosnia and Herzegovina and Ivana Čerkez, Pathology Resident at the University Clinical Center Tuzla, Bosnia and Herzegovina. This artwork draws from signet ring cell adenocarcinoma, a malignancy often arising in the gastrointestinal tract, symbolizing severe pathological consequences of disrupted cellular regulation within food-related organ systems.
Signet Ring Cell Adenocarcinoma by Aneta Vareškić, Molecular Biologist (Genetics) at the University Clinical Center Tuzla, Bosnia and Herzegovina and Ivana Čerkez, Pathology Resident at the University Clinical Center Tuzla, Bosnia and Herzegovina. This artwork draws from signet ring cell adenocarcinoma, a malignancy often arising in the gastrointestinal tract, symbolizing severe pathological consequences of disrupted cellular regulation within food-related organ systems.
Core by Celia Marginean, Baylor College of Medicine, Houston, Texas, USA. My diptych painting is made with acrylic and mixed media and presents a stylized interpretation of a cell. Overall, it explores cellular structures and patterns through obstruction, without aiming for a literal representation.
Core by Celia Marginean, Baylor College of Medicine, Houston, Texas, USA. My diptych painting is made with acrylic and mixed media and presents a stylized interpretation of a cell. Overall, it explores cellular structures and patterns through obstruction, without aiming for a literal representation.
Gross-but not gross by Javeria Nizam, Pathologists’ Assistant, Ontario, Canada. This illustration reflects the lived experiences behind the grossing bench – a tribute to Pathologists’ Assistants – whose work bridges science, skill, and quiet reverence for human tissue. From amputated fingers and inflamed appendices, to maggot-infested mastectomies and complex teratomas; from meticulously rolled placental membranes, to eyes affected by retinoblastoma, these specimens tell stories that linger. Often perceived as grotesque, this is a world of its own-one that is visible only to those who work within it.
Gross-but not gross by Javeria Nizam, Pathologists’ Assistant, Ontario, Canada. This illustration reflects the lived experiences behind the grossing bench – a tribute to Pathologists’ Assistants – whose work bridges science, skill, and quiet reverence for human tissue. From amputated fingers and inflamed appendices, to maggot-infested mastectomies and complex teratomas; from meticulously rolled placental membranes, to eyes affected by retinoblastoma, these specimens tell stories that linger. Often perceived as grotesque, this is a world of its own-one that is visible only to those who work within it.
Health Grows from What We Cultivate by Jessica Guzmán, Pathologist, Department of Anatomical Pathology, Hospital Julio Méndez, Buenos Aires, Argentina. Through this piece, I aim to raise awareness about food-related health through art. The painting reflects the idea that the food chain begins with environmental hygiene – care for the environment, soil protection, water quality, and responsible pesticide use – all of which are essential to preventing foodborne disease, a persistent global public health challenge. The image features a large, healthy tree whose branches form shrubs shaped like infradiaphragmatic organs involved in digestion, detoxification, and absorption. Each organ is divided into three sections, with histological tissues from other organs depicted within them, symbolizing interconnection – for example, pancreatic tissue within the kidney and colonic tissue within the spleen. I hope this work resonates with viewers worldwide, particularly patients and public authorities responsible for safeguarding food and environmental health.
Health Grows from What We Cultivate by Jessica Guzmán, Pathologist, Department of Anatomical Pathology, Hospital Julio Méndez, Buenos Aires, Argentina. Through this piece, I aim to raise awareness about food-related health through art. The painting reflects the idea that the food chain begins with environmental hygiene – care for the environment, soil protection, water quality, and responsible pesticide use – all of which are essential to preventing foodborne disease, a persistent global public health challenge. The image features a large, healthy tree whose branches form shrubs shaped like infradiaphragmatic organs involved in digestion, detoxification, and absorption. Each organ is divided into three sections, with histological tissues from other organs depicted within them, symbolizing interconnection – for example, pancreatic tissue within the kidney and colonic tissue within the spleen. I hope this work resonates with viewers worldwide, particularly patients and public authorities responsible for safeguarding food and environmental health.
Life Underneath a Lens by Krishi Patel, Biology Medical Science Masters Graduate, Georgia State University, US. This histology project is a painted collage on wood that explores the complexity and beauty of human life beneath the surface. The tissues that are featured are inspired by stains such as H&E, silver, aniline blue, trichrome, and elastin.
Life Underneath a Lens by Krishi Patel, Biology Medical Science Masters Graduate, Georgia State University, US. This histology project is a painted collage on wood that explores the complexity and beauty of human life beneath the surface. The tissues that are featured are inspired by stains such as H&E, silver, aniline blue, trichrome, and elastin.
The Big Five by Leonie Schön, Pathology Resident at the Institute of Pathology, Evangelisches Krankenhaus Oberhausen (EKO), Germany. This series of artworks comprises five oil paintings addressing the topic of cancer. It depicts the five most common cancer diagnoses worldwide according to the WHO (excluding non-melanoma skin cancer): colon, lung, breast, prostate, and stomach cancer. All paintings are oil on canvas and measure 70 × 80 cm.
The Big Five by Leonie Schön, Pathology Resident at the Institute of Pathology, Evangelisches Krankenhaus Oberhausen (EKO), Germany. This series of artworks comprises five oil paintings addressing the topic of cancer. It depicts the five most common cancer diagnoses worldwide according to the WHO (excluding non-melanoma skin cancer): colon, lung, breast, prostate, and stomach cancer. All paintings are oil on canvas and measure 70 × 80 cm.
The Big Five by Leonie Schön, Pathology Resident at the Institute of Pathology, Evangelisches Krankenhaus Oberhausen (EKO), Germany. This series of artworks comprises five oil paintings addressing the topic of cancer. It depicts the five most common cancer diagnoses worldwide according to the WHO (excluding non-melanoma skin cancer): colon, lung, breast, prostate, and stomach cancer. All paintings are oil on canvas and measure 70 × 80 cm.
The Big Five by Leonie Schön, Pathology Resident at the Institute of Pathology, Evangelisches Krankenhaus Oberhausen (EKO), Germany. This series of artworks comprises five oil paintings addressing the topic of cancer. It depicts the five most common cancer diagnoses worldwide according to the WHO (excluding non-melanoma skin cancer): colon, lung, breast, prostate, and stomach cancer. All paintings are oil on canvas and measure 70 × 80 cm.
The Big Five by Leonie Schön, Pathology Resident at the Institute of Pathology, Evangelisches Krankenhaus Oberhausen (EKO), Germany. This series of artworks comprises five oil paintings addressing the topic of cancer. It depicts the five most common cancer diagnoses worldwide according to the WHO (excluding non-melanoma skin cancer): colon, lung, breast, prostate, and stomach cancer. All paintings are oil on canvas and measure 70 × 80 cm.
The Big Five by Leonie Schön, Pathology Resident at the Institute of Pathology, Evangelisches Krankenhaus Oberhausen (EKO), Germany. This series of artworks comprises five oil paintings addressing the topic of cancer. It depicts the five most common cancer diagnoses worldwide according to the WHO (excluding non-melanoma skin cancer): colon, lung, breast, prostate, and stomach cancer. All paintings are oil on canvas and measure 70 × 80 cm.
The Big Five by Leonie Schön, Pathology Resident at the Institute of Pathology, Evangelisches Krankenhaus Oberhausen (EKO), Germany. This series of artworks comprises five oil paintings addressing the topic of cancer. It depicts the five most common cancer diagnoses worldwide according to the WHO (excluding non-melanoma skin cancer): colon, lung, breast, prostate, and stomach cancer. All paintings are oil on canvas and measure 70 × 80 cm.
The Big Five by Leonie Schön, Pathology Resident at the Institute of Pathology, Evangelisches Krankenhaus Oberhausen (EKO), Germany. This series of artworks comprises five oil paintings addressing the topic of cancer. It depicts the five most common cancer diagnoses worldwide according to the WHO (excluding non-melanoma skin cancer): colon, lung, breast, prostate, and stomach cancer. All paintings are oil on canvas and measure 70 × 80 cm.
The Big Five by Leonie Schön, Pathology Resident at the Institute of Pathology, Evangelisches Krankenhaus Oberhausen (EKO), Germany. This series of artworks comprises five oil paintings addressing the topic of cancer. It depicts the five most common cancer diagnoses worldwide according to the WHO (excluding non-melanoma skin cancer): colon, lung, breast, prostate, and stomach cancer. All paintings are oil on canvas and measure 70 × 80 cm.
The Big Five by Leonie Schön, Pathology Resident at the Institute of Pathology, Evangelisches Krankenhaus Oberhausen (EKO), Germany. This series of artworks comprises five oil paintings addressing the topic of cancer. It depicts the five most common cancer diagnoses worldwide according to the WHO (excluding non-melanoma skin cancer): colon, lung, breast, prostate, and stomach cancer. All paintings are oil on canvas and measure 70 × 80 cm.
Pathogen Quartet by Lynne Altow, Medical Student, University of British Columbia, Canada. This watercolour piece highlights the four leading causes of food-borne deaths in Canada. These include Listeria monocytogenes, norovirus, non-typhoidal Salmonella spp., and Escherichia coli 0157 (Public Health Agency of Canada, 2016).
Pathogen Quartet by Lynne Altow, Medical Student, University of British Columbia, Canada. This watercolour piece highlights the four leading causes of food-borne deaths in Canada. These include Listeria monocytogenes, norovirus, non-typhoidal Salmonella spp., and Escherichia coli 0157 (Public Health Agency of Canada, 2016).
Pathogens Mosaic by Lynne Altow, Medical Student, University of British Columbia, Canada. This watercolour piece displays common food-borne pathogens in gram-stain and electron micrograph form across washes of pinks, purples, and blues.
Pathogens Mosaic by Lynne Altow, Medical Student, University of British Columbia, Canada. This watercolour piece displays common food-borne pathogens in gram-stain and electron micrograph form across washes of pinks, purples, and blues.
PAS-Positive Stain of variant Creutzfeldt–Jakob disease (vCJD) by Marisol D. Gomez, M.S. Candidate & Microbiology GTA within the Department of Biological Sciences at The University of Alabama, Tuscaloosa, Alabama, USA. Periodic acid–Schiff (PAS)–positive depiction of variant Creutzfeldt–Jakob disease (vCJD), illustrating characteristic florid plaques surrounded by spongiform vacuolation within the cerebral cortex. Acrylic on canvas, 24 × 24 inches.
PAS-Positive Stain of variant Creutzfeldt–Jakob disease (vCJD) by Marisol D. Gomez, M.S. Candidate & Microbiology GTA within the Department of Biological Sciences at The University of Alabama, Tuscaloosa, Alabama, USA. Periodic acid–Schiff (PAS)–positive depiction of variant Creutzfeldt–Jakob disease (vCJD), illustrating characteristic florid plaques surrounded by spongiform vacuolation within the cerebral cortex. Acrylic on canvas, 24 × 24 inches.
Divide & Conquer by Mattie Grace Neighbors, first year medical student at the University of Arkansas for Medical Sciences, US. 8x10 watercolor depicting mitosis.
Divide & Conquer by Mattie Grace Neighbors, first year medical student at the University of Arkansas for Medical Sciences, US. 8x10 watercolor depicting mitosis.
Viva La Villi by Mattie Grace Neighbors, first year medical student at the University of Arkansas for Medical Sciences, US. 8x10 watercolor depicting intestinal villi.
Viva La Villi by Mattie Grace Neighbors, first year medical student at the University of Arkansas for Medical Sciences, US. 8x10 watercolor depicting intestinal villi.
Kary on by Mattie Grace Neighbors, first year medical student at the University of Arkansas for Medical Sciences, US. 4x6 acrylic depicting a human karyotype.
Kary on by Mattie Grace Neighbors, first year medical student at the University of Arkansas for Medical Sciences, US. 4x6 acrylic depicting a human karyotype.
Through the Lens of Perseverance by Mattie Grace Neighbors, first year medical student at the University of Arkansas for Medical Sciences, US. 16x20 acrylic.
Through the Lens of Perseverance by Mattie Grace Neighbors, first year medical student at the University of Arkansas for Medical Sciences, US. 16x20 acrylic.
Through their gift, we see within by Mattie Grace Neighbors, first year medical student at the University of Arkansas for Medical Sciences, US. 6x6 digital.
Through their gift, we see within by Mattie Grace Neighbors, first year medical student at the University of Arkansas for Medical Sciences, US. 6x6 digital.
The Birth of Blood by Meredith K Herman, Pathology Resident at the University of Michigan, USA. This vibrant gouache artwork depicts the dynamic process of hematopoiesis, where new blood cells are born from hematopoietic stem cells. The purple and pink spheres represent developing blood cell precursors, clustered and layered in a lively dance reminiscent of bone marrow under a microscope. Splashes of blue and white evoke the ever-changing microenvironment, highlighting the diversity and energy within this essential site of cellular renewal.
The Birth of Blood by Meredith K Herman, Pathology Resident at the University of Michigan, USA. This vibrant gouache artwork depicts the dynamic process of hematopoiesis, where new blood cells are born from hematopoietic stem cells. The purple and pink spheres represent developing blood cell precursors, clustered and layered in a lively dance reminiscent of bone marrow under a microscope. Splashes of blue and white evoke the ever-changing microenvironment, highlighting the diversity and energy within this essential site of cellular renewal.
Collagen Currents & Epidermal Waves by Meredith K Herman, Pathology Resident at the University of Michigan, USA. This striking painting with gouache captures the nuanced architecture of skin as seen through a trichrome stain. Vivid pinks and purples depict the tightly packed layers of the epidermis, illustrating the protective outer barrier. Below, the intricate blue hues represent the collagen-rich matrix of the dermis, emphasizing the supportive framework and connective tissue vital for skin strength and resilience. The flowing boundaries between these layers reflect the harmonious relationship between the epidermis and dermis in maintaining the integrity of our body’s largest organ.
Collagen Currents & Epidermal Waves by Meredith K Herman, Pathology Resident at the University of Michigan, USA. This striking painting with gouache captures the nuanced architecture of skin as seen through a trichrome stain. Vivid pinks and purples depict the tightly packed layers of the epidermis, illustrating the protective outer barrier. Below, the intricate blue hues represent the collagen-rich matrix of the dermis, emphasizing the supportive framework and connective tissue vital for skin strength and resilience. The flowing boundaries between these layers reflect the harmonious relationship between the epidermis and dermis in maintaining the integrity of our body’s largest organ.
From Source to Cell: What Food Safety Leaves Behind by Michele Mitchell, Patient Advocate, ASCP Patient Champion, Michigan, USA. This artwork reflects the hidden journey of environmental contaminants through food and water systems and into the human body. The composition moves from natural abundance – fish, fruit, and flowing water – to microscopic cellular patterns shaped by persistent chemical exposure. What appears safe and nourishing at the surface slowly transforms into digitized pathology within her body, revealing the unseen consequences of what we consume. The patient figure anchors the work, representing lived experience as a breast cancer survivor and intersecting with scientific discoveries that forever chemicals and plastics may bring to her life. Subtle molecular and cellular motifs evoke PFAS exposure, emphasizing persistence rather than toxicity alone. Pathology serves as the bridge between environment and understanding – translating invisible risk into evidence that patients and clinicians can see, interpret, and act upon. This piece honors pathology’s essential role in food safety: safeguarding public health by uncovering what inspection cannot, tracing exposure from source to cell to cancer causing diseases giving patients clarity where uncertainty once lived.
From Source to Cell: What Food Safety Leaves Behind by Michele Mitchell, Patient Advocate, ASCP Patient Champion, Michigan, USA. This artwork reflects the hidden journey of environmental contaminants through food and water systems and into the human body. The composition moves from natural abundance – fish, fruit, and flowing water – to microscopic cellular patterns shaped by persistent chemical exposure. What appears safe and nourishing at the surface slowly transforms into digitized pathology within her body, revealing the unseen consequences of what we consume. The patient figure anchors the work, representing lived experience as a breast cancer survivor and intersecting with scientific discoveries that forever chemicals and plastics may bring to her life. Subtle molecular and cellular motifs evoke PFAS exposure, emphasizing persistence rather than toxicity alone. Pathology serves as the bridge between environment and understanding – translating invisible risk into evidence that patients and clinicians can see, interpret, and act upon. This piece honors pathology’s essential role in food safety: safeguarding public health by uncovering what inspection cannot, tracing exposure from source to cell to cancer causing diseases giving patients clarity where uncertainty once lived.
Path Yin Yang by Misha Dalal, Pathology Resident, Department of Pathology, University of Illinois at Chicago, USA. Depicting colonic morphology on H&E alongside corresponding features under fluorescent immunofluorescence.
Path Yin Yang by Misha Dalal, Pathology Resident, Department of Pathology, University of Illinois at Chicago, USA. Depicting colonic morphology on H&E alongside corresponding features under fluorescent immunofluorescence.
Symphony of Blood Cells by Nithya Jayakumar, Pathologist at Bettadur Diagnostics, Raichur, Karnataka, India. Original handmade painting in watercolor.
Symphony of Blood Cells by Nithya Jayakumar, Pathologist at Bettadur Diagnostics, Raichur, Karnataka, India. Original handmade painting in watercolor.
From Cell to Diagnosis by Nithya Jayakumar, Pathologist at Bettadur Diagnostics, Raichur, Karnataka, India. Original handmade painting in acrylic medium on canvas.
From Cell to Diagnosis by Nithya Jayakumar, Pathologist at Bettadur Diagnostics, Raichur, Karnataka, India. Original handmade painting in acrylic medium on canvas.
Under the Microscope, Curiosity Grows Wings by Nithya Jayakumar, Pathologist at Bettadur Diagnostics, Raichur, Karnataka, India. Original handmade painting in acrylic medium on canvas.
Under the Microscope, Curiosity Grows Wings by Nithya Jayakumar, Pathologist at Bettadur Diagnostics, Raichur, Karnataka, India. Original handmade painting in acrylic medium on canvas.
Peripheral nerve by Pranjali Mandurkar, Oral and Maxillofacial Pathologist, Goa Dental College and Hospital, India. A monochromatic sketch of a cross-section of peripheral nerve using micro pigment ink.
Peripheral nerve by Pranjali Mandurkar, Oral and Maxillofacial Pathologist, Goa Dental College and Hospital, India. A monochromatic sketch of a cross-section of peripheral nerve using micro pigment ink.
Vascular pathology by Pranjali Mandurkar, Oral and Maxillofacial Pathologist, Goa Dental College and Hospital, India. A watercolour painting depicting a vascular lesion.
Vascular pathology by Pranjali Mandurkar, Oral and Maxillofacial Pathologist, Goa Dental College and Hospital, India. A watercolour painting depicting a vascular lesion.
Osteoclasts by Pranjali Mandurkar, Oral and Maxillofacial Pathologist, Goa Dental College and Hospital, India. A watercolour artwork illustrating osteoclasts in the process of bone resorption.
Osteoclasts by Pranjali Mandurkar, Oral and Maxillofacial Pathologist, Goa Dental College and Hospital, India. A watercolour artwork illustrating osteoclasts in the process of bone resorption.
Safe Food Saves Health by Samina Khan Bhatty, Assistant Principal Woman Medical Officer and Medical Superintendent THQ hospital kahuta, Pakistan. Watercolor painting on A3-sized, 300-g/m² paper, depicting the importance of food safety through proper food selection, washing with clean water, separating different food items, and cooking and chilling foods at appropriate temperatures. Rotten food should be discarded, as pathogenic organisms such as Salmonella, Escherichia coli, molds, norovirus, rotavirus, hepatitis A virus, and parasites like Giardia can contaminate food and cause foodborne disease. Prevention through food safety is far better than treatment – safe food saves health.
Safe Food Saves Health by Samina Khan Bhatty, Assistant Principal Woman Medical Officer and Medical Superintendent THQ hospital kahuta, Pakistan. Watercolor painting on A3-sized, 300-g/m² paper, depicting the importance of food safety through proper food selection, washing with clean water, separating different food items, and cooking and chilling foods at appropriate temperatures. Rotten food should be discarded, as pathogenic organisms such as Salmonella, Escherichia coli, molds, norovirus, rotavirus, hepatitis A virus, and parasites like Giardia can contaminate food and cause foodborne disease. Prevention through food safety is far better than treatment – safe food saves health.
Cervical pap smear with Candida infection by Selim Surer, PGY-1 pathology resident at Malatya Inonu University, Turkey. I combine visually aesthetic histopathological images I come across during my training with traditional handmade tilework; to my knowledge, it could be a world first. It is a way to express my love for pathology and keep in touch with my heritage.
Cervical pap smear with Candida infection by Selim Surer, PGY-1 pathology resident at Malatya Inonu University, Turkey. I combine visually aesthetic histopathological images I come across during my training with traditional handmade tilework; to my knowledge, it could be a world first. It is a way to express my love for pathology and keep in touch with my heritage.
Field of Flowers - Colonic Crypts by Selim Surer, PGY-1 pathology resident at Malatya Inonu University, Turkey. I combine visually aesthetic histopathological images I come across during my training with traditional handmade tilework; to my knowledge, it could be a world first. It is a way to express my love for pathology and keep in touch with my heritage.
Field of Flowers - Colonic Crypts by Selim Surer, PGY-1 pathology resident at Malatya Inonu University, Turkey. I combine visually aesthetic histopathological images I come across during my training with traditional handmade tilework; to my knowledge, it could be a world first. It is a way to express my love for pathology and keep in touch with my heritage.
Peripheral blood smear with a central mast cell by Selim Surer, PGY-1 pathology resident at Malatya Inonu University, Turkey. I combine visually aesthetic histopathological images I come across during my training with traditional handmade tilework; to my knowledge, it could be a world first. It is a way to express my love for pathology and keep in touch with my heritage.
Peripheral blood smear with a central mast cell by Selim Surer, PGY-1 pathology resident at Malatya Inonu University, Turkey. I combine visually aesthetic histopathological images I come across during my training with traditional handmade tilework; to my knowledge, it could be a world first. It is a way to express my love for pathology and keep in touch with my heritage.
Retina by Selim Surer, PGY-1 pathology resident at Malatya Inonu University, Turkey. I combine visually aesthetic histopathological images I come across during my training with traditional handmade tilework; to my knowledge, it could be a world first. It is a way to express my love for pathology and keep in touch with my heritage.
Retina by Selim Surer, PGY-1 pathology resident at Malatya Inonu University, Turkey. I combine visually aesthetic histopathological images I come across during my training with traditional handmade tilework; to my knowledge, it could be a world first. It is a way to express my love for pathology and keep in touch with my heritage.
Seborrheic keratosis by Selim Surer, PGY-1 pathology resident at Malatya Inonu University, Turkey. I combine visually aesthetic histopathological images I come across during my training with traditional handmade tilework; to my knowledge, it could be a world first. It is a way to express my love for pathology and keep in touch with my heritage.
Seborrheic keratosis by Selim Surer, PGY-1 pathology resident at Malatya Inonu University, Turkey. I combine visually aesthetic histopathological images I come across during my training with traditional handmade tilework; to my knowledge, it could be a world first. It is a way to express my love for pathology and keep in touch with my heritage.
Lunch in the Lung (watercolour) by Suhashini Ganapaty, Anatomic Pathologist, Hospital Sultan Idris Shah, Malaysia. Seed storage cell granuloma caused by aspirated legume within the airway, surrounded by multinucleated giant cells with type 2 pneumocyte hyperplasia and organising pneumonia.
Lunch in the Lung (watercolour) by Suhashini Ganapaty, Anatomic Pathologist, Hospital Sultan Idris Shah, Malaysia. Seed storage cell granuloma caused by aspirated legume within the airway, surrounded by multinucleated giant cells with type 2 pneumocyte hyperplasia and organising pneumonia.
Food Safety Breach from a Histopathologist’s Microscope by Uzma Aslam, Consultant Histopathologist, Social Security hospital Multan Chungi, Lahore, Pakistan. My drawings focus on infectious and foodborne diseases that result from breaches in food safety. As a histopathologist, I encounter these cases in practice, some of them quite frequently. Through my artwork, I aim to show how these conditions appear under the microscope and how they damage different organs, alongside pictorial representations of selected etiologic sources.
Food Safety Breach from a Histopathologist’s Microscope by Uzma Aslam, Consultant Histopathologist, Social Security hospital Multan Chungi, Lahore, Pakistan. My drawings focus on infectious and foodborne diseases that result from breaches in food safety. As a histopathologist, I encounter these cases in practice, some of them quite frequently. Through my artwork, I aim to show how these conditions appear under the microscope and how they damage different organs, alongside pictorial representations of selected etiologic sources.
Acute Leukemia by Virginia Fernandez, Pathology Resident, Department of Pathology and Laboratory Medicine, University of Miami Health System/Jackson Memorial Hospital, USA. Large immature blasts crowd the field, replacing normal bone marrow cells. Their dark nuclei and minimal cytoplasm reflect rapid, uncontrolled growth and a failure of normal white blood cell maturation. Watercolor illustration.
Acute Leukemia by Virginia Fernandez, Pathology Resident, Department of Pathology and Laboratory Medicine, University of Miami Health System/Jackson Memorial Hospital, USA. Large immature blasts crowd the field, replacing normal bone marrow cells. Their dark nuclei and minimal cytoplasm reflect rapid, uncontrolled growth and a failure of normal white blood cell maturation. Watercolor illustration.
Acute Promyelocytic Leukemia by Virginia Fernandez, Pathology Resident, Department of Pathology and Laboratory Medicine, University of Miami Health System/Jackson Memorial Hospital, USA. Abnormal promyelocytes fill the field, with folded nuclei and dense cytoplasmic granules. Slender Auer rods hint at the dangerous coagulopathy that makes this leukemia a true hematologic emergency. Watercolor illustration.
Acute Promyelocytic Leukemia by Virginia Fernandez, Pathology Resident, Department of Pathology and Laboratory Medicine, University of Miami Health System/Jackson Memorial Hospital, USA. Abnormal promyelocytes fill the field, with folded nuclei and dense cytoplasmic granules. Slender Auer rods hint at the dangerous coagulopathy that makes this leukemia a true hematologic emergency. Watercolor illustration.
Chronic Myeloid Leukemia by Virginia Fernandez, Pathology Resident, Department of Pathology and Laboratory Medicine, University of Miami Health System/Jackson Memorial Hospital, USA. A full spectrum of maturing myeloid cells fills the field, from immature precursors to segmented neutrophils, reflecting disordered but ongoing granulocytic proliferation. Watercolor illustration.
Chronic Myeloid Leukemia by Virginia Fernandez, Pathology Resident, Department of Pathology and Laboratory Medicine, University of Miami Health System/Jackson Memorial Hospital, USA. A full spectrum of maturing myeloid cells fills the field, from immature precursors to segmented neutrophils, reflecting disordered but ongoing granulocytic proliferation. Watercolor illustration.
Hairy Cell Leukemia by Virginia Fernandez, Pathology Resident, Department of Pathology and Laboratory Medicine, University of Miami Health System/Jackson Memorial Hospital, USA. Large lymphoid cells with abundant pale cytoplasm and irregular borders dominate the field, giving rise to the characteristic “hairy” appearance. Watercolor illustration.
Hairy Cell Leukemia by Virginia Fernandez, Pathology Resident, Department of Pathology and Laboratory Medicine, University of Miami Health System/Jackson Memorial Hospital, USA. Large lymphoid cells with abundant pale cytoplasm and irregular borders dominate the field, giving rise to the characteristic “hairy” appearance. Watercolor illustration.
Erythroid Precursors by Virginia Fernandez, Pathology Resident, Department of Pathology and Laboratory Medicine, University of Miami Health System/Jackson Memorial Hospital, USA. Numerous erythroblasts at different stages of maturation fill the field, showing round nuclei and deeply basophilic cytoplasm typical of erythroid lineage.
Erythroid Precursors by Virginia Fernandez, Pathology Resident, Department of Pathology and Laboratory Medicine, University of Miami Health System/Jackson Memorial Hospital, USA. Numerous erythroblasts at different stages of maturation fill the field, showing round nuclei and deeply basophilic cytoplasm typical of erythroid lineage.
Before the First Bite by Zohre Sadeghian, Clinical Research Fellow, Department of Pathology and Laboratory Medicine, Cleveland Clinic, Florida, USA. Food safety begins long before a meal reaches the table – within unseen ecosystems where microbes, host tissues, and immune defenses interact. This artwork imagines the microscope as a watchtower, scanning a vivid landscape of cells, tissues, and organisms to detect what the naked eye cannot: contamination, spoilage, and foodborne disease. It is a tribute to pathologists and laboratory teams who turn microscopic patterns into actionable evidence through monitoring and early detection, helping protect communities “before the first bite.” Created on a 16 × 20-inch (40 × 50 cm) canvas using acrylic paint, the piece was developed carefully over several weeks. Each section highlights either a histological view of healthy tissue or a pathological view of diseased tissue.
Before the First Bite by Zohre Sadeghian, Clinical Research Fellow, Department of Pathology and Laboratory Medicine, Cleveland Clinic, Florida, USA. Food safety begins long before a meal reaches the table – within unseen ecosystems where microbes, host tissues, and immune defenses interact. This artwork imagines the microscope as a watchtower, scanning a vivid landscape of cells, tissues, and organisms to detect what the naked eye cannot: contamination, spoilage, and foodborne disease. It is a tribute to pathologists and laboratory teams who turn microscopic patterns into actionable evidence through monitoring and early detection, helping protect communities “before the first bite.” Created on a 16 × 20-inch (40 × 50 cm) canvas using acrylic paint, the piece was developed carefully over several weeks. Each section highlights either a histological view of healthy tissue or a pathological view of diseased tissue.
Slide Images
Verruca Vulgaris: No Filter Series by A. Sarah Erem, Dermatopathology Fellow at Columbia University, New York, USA. Classic Histology, Zero Boredom. Koilocytes: Myth, Legend, or Artifact?
Verruca Vulgaris: No Filter Series by A. Sarah Erem, Dermatopathology Fellow at Columbia University, New York, USA. Classic Histology, Zero Boredom. Koilocytes: Myth, Legend, or Artifact?
Pop-pathart by Aurélien Morini, Hospital Practitioner and Head of the Pathology Laboratory Department (Biopathology Division), GHEF, Marne-la-Vallée, Jossigny, France. This image merges a photo of red blood cells – enhanced with an app filter – that gives it the feel of a pop art–style painting.
Pop-pathart by Aurélien Morini, Hospital Practitioner and Head of the Pathology Laboratory Department (Biopathology Division), GHEF, Marne-la-Vallée, Jossigny, France. This image merges a photo of red blood cells – enhanced with an app filter – that gives it the feel of a pop art–style painting.
Flowers, Everywhere by Aurélien Morini, Hospital Practitioner and Head of the Pathology Laboratory Department (Biopathology Division), GHEF, Marne-la-Vallée, Jossigny, France. This image merges a photo of mammary apocrine cysts with one of a field of tulips.
Flowers, Everywhere by Aurélien Morini, Hospital Practitioner and Head of the Pathology Laboratory Department (Biopathology Division), GHEF, Marne-la-Vallée, Jossigny, France. This image merges a photo of mammary apocrine cysts with one of a field of tulips.
Coeurville-sur-mer: French romantic seaside resort? by Aurélien Morini, Hospital Practitioner and Head of the Pathology Laboratory Department (Biopathology Division), GHEF, Marne-la-Vallée, Jossigny, France. This image merges a photo of a heart-shaped specimen with a specific app filter. The blue tones reminded me of the sea, and since I was in Normandy at the time, I came up with the name of a fictional seaside resort – one that could almost exist.
Coeurville-sur-mer: French romantic seaside resort? by Aurélien Morini, Hospital Practitioner and Head of the Pathology Laboratory Department (Biopathology Division), GHEF, Marne-la-Vallée, Jossigny, France. This image merges a photo of a heart-shaped specimen with a specific app filter. The blue tones reminded me of the sea, and since I was in Normandy at the time, I came up with the name of a fictional seaside resort – one that could almost exist.
CauliBrain by Dalia Ahmed Yousef Yehia, Lecturer of Medical Histology and Cell Biology, Faculty of Medicine at Ain Shams University, Cairo, Egypt. Brain H&E x100. The resemblance between the cauliflower cut section and the brain cut section is amazing.
CauliBrain by Dalia Ahmed Yousef Yehia, Lecturer of Medical Histology and Cell Biology, Faculty of Medicine at Ain Shams University, Cairo, Egypt. Brain H&E x100. The resemblance between the cauliflower cut section and the brain cut section is amazing.
VasTomato by Dalia Ahmed Yousef Yehia, Lecturer of Medical Histology and Cell Biology, Faculty of Medicine at Ain Shams University, Cairo, Egypt. Vas Deferens H&E x100. I was cutting some tomatoes for some delicious homemade pizza and it struck me that the lumen and lining of the Vas Deferens is pretty similar to the heart of the tomato.
VasTomato by Dalia Ahmed Yousef Yehia, Lecturer of Medical Histology and Cell Biology, Faculty of Medicine at Ain Shams University, Cairo, Egypt. Vas Deferens H&E x100. I was cutting some tomatoes for some delicious homemade pizza and it struck me that the lumen and lining of the Vas Deferens is pretty similar to the heart of the tomato.
The Classic Carrot Lobule by Dalia Ahmed Yousef Yehia, Lecturer of Medical Histology and Cell Biology, Faculty of Medicine at Ain Shams University, Cairo, Egypt. Liver H&E x100. Patterns are the same everywhere! The classic hepatic lobule is the unit block of the liver tissue, it has a central vein and hepatocytes arranged in linear cords from the central vein in the same pattern of the heart of the carrot.
The Classic Carrot Lobule by Dalia Ahmed Yousef Yehia, Lecturer of Medical Histology and Cell Biology, Faculty of Medicine at Ain Shams University, Cairo, Egypt. Liver H&E x100. Patterns are the same everywhere! The classic hepatic lobule is the unit block of the liver tissue, it has a central vein and hepatocytes arranged in linear cords from the central vein in the same pattern of the heart of the carrot.
The Kiwi like Jejunum by Dalia Ahmed Yousef Yehia, Lecturer of Medical Histology and Cell Biology, Faculty of Medicine at Ain Shams University, Cairo, Egypt. Jejunum H&E x40. The patterns under the microscope are everywhere around us. Half jejunum, half kiwi. Notice the finger like projections/villi of this part of the small intestine.
The Kiwi like Jejunum by Dalia Ahmed Yousef Yehia, Lecturer of Medical Histology and Cell Biology, Faculty of Medicine at Ain Shams University, Cairo, Egypt. Jejunum H&E x40. The patterns under the microscope are everywhere around us. Half jejunum, half kiwi. Notice the finger like projections/villi of this part of the small intestine.
The Hair Cantaloupe by Dalia Ahmed Yousef Yehia, Lecturer of Medical Histology and Cell Biology, Faculty of Medicine at Ain Shams University, Cairo, Egypt. Hair follicle x400 H&E. Hair follicles tangentially cut a beauty like the core of the cantaloupe – yummy indeed.
The Hair Cantaloupe by Dalia Ahmed Yousef Yehia, Lecturer of Medical Histology and Cell Biology, Faculty of Medicine at Ain Shams University, Cairo, Egypt. Hair follicle x400 H&E. Hair follicles tangentially cut a beauty like the core of the cantaloupe – yummy indeed.
Cucumber Villi by Dalia Ahmed Yousef Yehia, Lecturer of Medical Histology and Cell Biology, Faculty of Medicine at Ain Shams University, Cairo, Egypt. Duodenum Villi x400 H&E slide. What a resemblance between the cucumber and intestinal villi – even the seeds look like the columnar epithelium nuclei and goblet cells.
Cucumber Villi by Dalia Ahmed Yousef Yehia, Lecturer of Medical Histology and Cell Biology, Faculty of Medicine at Ain Shams University, Cairo, Egypt. Duodenum Villi x400 H&E slide. What a resemblance between the cucumber and intestinal villi – even the seeds look like the columnar epithelium nuclei and goblet cells.
Diagnosis: True saviour of life by Deepa Nagarajan, Resident DM Oncopathology third year, Gujarat cancer and research institute, Ahmedabad, Gujarat, India. A patient is lost in a pool of mucin, symbolizing diagnostic uncertainty, and is guided to safety as the microscope transforms into a lighthouse – casting the light of diagnosis that leads the doctor to save a life.
Diagnosis: True saviour of life by Deepa Nagarajan, Resident DM Oncopathology third year, Gujarat cancer and research institute, Ahmedabad, Gujarat, India. A patient is lost in a pool of mucin, symbolizing diagnostic uncertainty, and is guided to safety as the microscope transforms into a lighthouse – casting the light of diagnosis that leads the doctor to save a life.
Find the Bunny by Erlin Haacke, Pathologie Friesland, The Netherlands. Every year I send my colleagues a happy bunny for the Easter holidays. It is one of my favorite holidays and it always brings a smile to their faces.
Find the Bunny by Erlin Haacke, Pathologie Friesland, The Netherlands. Every year I send my colleagues a happy bunny for the Easter holidays. It is one of my favorite holidays and it always brings a smile to their faces.
The Cat in the Hat by Felipe S. Templo, Jr, Philippine Heart Center, Philippines. This is an H&E stained bronchial biopsy from a 59 year old man.
The Cat in the Hat by Felipe S. Templo, Jr, Philippine Heart Center, Philippines. This is an H&E stained bronchial biopsy from a 59 year old man.
Colonic Adenomas Are as Ancient as Dinosaurs by Ioana Dumitru, Freelance Pathologist, France. Tubular colonic adenoma with low grade dysplasia with complete excision.
Colonic Adenomas Are as Ancient as Dinosaurs by Ioana Dumitru, Freelance Pathologist, France. Tubular colonic adenoma with low grade dysplasia with complete excision.
Colonoscopy Can Sometimes Be Scary by Ioana Dumitru, Freelance Pathologist, France. When Mike Wazowski, a one-eyed cyclops, incarnates a tubular colonic adenoma with low-grade dysplasia, his pal James P. Sullivan joins him for the ride during colonoscopy.
Colonoscopy Can Sometimes Be Scary by Ioana Dumitru, Freelance Pathologist, France. When Mike Wazowski, a one-eyed cyclops, incarnates a tubular colonic adenoma with low-grade dysplasia, his pal James P. Sullivan joins him for the ride during colonoscopy.
Lightning Strikes by Jason Innerhofer, Pathologists’ Assistant, Pathology Associates of Albuquerque, Presbyterian Healthcare Services, Albuquerque, New Mexico, USA. Captured with digital pathology.
Lightning Strikes by Jason Innerhofer, Pathologists’ Assistant, Pathology Associates of Albuquerque, Presbyterian Healthcare Services, Albuquerque, New Mexico, USA. Captured with digital pathology.
Dental Cells and the Mechanics of Safe Eating by Mariana Villarroel-Dorrego, Universidad Santa Maria/Universidad Central de Venezuela, Caracas-Venezuela. Food safety is often viewed through the lens of contaminants, but it begins with the biological integrity of our digestive system. These H&E stained sections reveal the specialized dental cells that form the structural basis of mastication – the very first step in safe and effective human nutrition.
Dental Cells and the Mechanics of Safe Eating by Mariana Villarroel-Dorrego, Universidad Santa Maria/Universidad Central de Venezuela, Caracas-Venezuela. Food safety is often viewed through the lens of contaminants, but it begins with the biological integrity of our digestive system. These H&E stained sections reveal the specialized dental cells that form the structural basis of mastication – the very first step in safe and effective human nutrition.
Dental Cells and the Mechanics of Safe Eating by Mariana Villarroel-Dorrego, Universidad Santa Maria/Universidad Central de Venezuela, Caracas-Venezuela. Food safety is often viewed through the lens of contaminants, but it begins with the biological integrity of our digestive system. These H&E stained sections reveal the specialized dental cells that form the structural basis of mastication – the very first step in safe and effective human nutrition.
Dental Cells and the Mechanics of Safe Eating by Mariana Villarroel-Dorrego, Universidad Santa Maria/Universidad Central de Venezuela, Caracas-Venezuela. Food safety is often viewed through the lens of contaminants, but it begins with the biological integrity of our digestive system. These H&E stained sections reveal the specialized dental cells that form the structural basis of mastication – the very first step in safe and effective human nutrition.
Dental Cells and the Mechanics of Safe Eating by Mariana Villarroel-Dorrego, Universidad Santa Maria/Universidad Central de Venezuela, Caracas-Venezuela. Food safety is often viewed through the lens of contaminants, but it begins with the biological integrity of our digestive system. These H&E stained sections reveal the specialized dental cells that form the structural basis of mastication – the very first step in safe and effective human nutrition.
Dental Cells and the Mechanics of Safe Eating by Mariana Villarroel-Dorrego, Universidad Santa Maria/Universidad Central de Venezuela, Caracas-Venezuela. Food safety is often viewed through the lens of contaminants, but it begins with the biological integrity of our digestive system. These H&E stained sections reveal the specialized dental cells that form the structural basis of mastication – the very first step in safe and effective human nutrition.
Dental Cells and the Mechanics of Safe Eating by Mariana Villarroel-Dorrego, Universidad Santa Maria/Universidad Central de Venezuela, Caracas-Venezuela. Food safety is often viewed through the lens of contaminants, but it begins with the biological integrity of our digestive system. These H&E stained sections reveal the specialized dental cells that form the structural basis of mastication – the very first step in safe and effective human nutrition.
Dental Cells and the Mechanics of Safe Eating by Mariana Villarroel-Dorrego, Universidad Santa Maria/Universidad Central de Venezuela, Caracas-Venezuela. Food safety is often viewed through the lens of contaminants, but it begins with the biological integrity of our digestive system. These H&E stained sections reveal the specialized dental cells that form the structural basis of mastication – the very first step in safe and effective human nutrition.
Dental Cells and the Mechanics of Safe Eating by Mariana Villarroel-Dorrego, Universidad Santa Maria/Universidad Central de Venezuela, Caracas-Venezuela. Food safety is often viewed through the lens of contaminants, but it begins with the biological integrity of our digestive system. These H&E stained sections reveal the specialized dental cells that form the structural basis of mastication – the very first step in safe and effective human nutrition.
Dental Cells and the Mechanics of Safe Eating by Mariana Villarroel-Dorrego, Universidad Santa Maria/Universidad Central de Venezuela, Caracas-Venezuela. Food safety is often viewed through the lens of contaminants, but it begins with the biological integrity of our digestive system. These H&E stained sections reveal the specialized dental cells that form the structural basis of mastication – the very first step in safe and effective human nutrition.
H&E Bouquet by Megha Lalcheta, MD Pathology Assistant Professor at MP Shah medical college, Jamnagar, India. The left upper image is from lymphoma of the kidney (normal glomerulus surrounded by sheets of malignant lymphoid cells). The left lower image is of a bouquet of beautiful purple and pink roses, alstroemeria, and daisies. And the right image is my #pathart. My ultimate imagination of making this glomerulus into a rose bouquet.
H&E Bouquet by Megha Lalcheta, MD Pathology Assistant Professor at MP Shah medical college, Jamnagar, India. The left upper image is from lymphoma of the kidney (normal glomerulus surrounded by sheets of malignant lymphoid cells). The left lower image is of a bouquet of beautiful purple and pink roses, alstroemeria, and daisies. And the right image is my #pathart. My ultimate imagination of making this glomerulus into a rose bouquet.
Unseen (CLL) by Muhammad Zunoorain Ali, Allama Iqbal medical college Lahore, Pakistan. Photographs of blood cells captured in a unique way, highlighting their patterns, structure, and the differences between normal and abnormal blood cells at the microscopic level.
Unseen (CLL) by Muhammad Zunoorain Ali, Allama Iqbal medical college Lahore, Pakistan. Photographs of blood cells captured in a unique way, highlighting their patterns, structure, and the differences between normal and abnormal blood cells at the microscopic level.
Never goes unnoticed (CML) by Muhammad Zunoorain Ali, Allama Iqbal medical college Lahore, Pakistan. Photographs of blood cells captured in a unique way, highlighting their patterns, structure, and the differences between normal and abnormal blood cells at the microscopic level.
Never goes unnoticed (CML) by Muhammad Zunoorain Ali, Allama Iqbal medical college Lahore, Pakistan. Photographs of blood cells captured in a unique way, highlighting their patterns, structure, and the differences between normal and abnormal blood cells at the microscopic level.
The Rosette Roadmap of Retinoblastoma by Poonam Arora Agrawal, Consultant Histopathologist, CentraPath labs, Indore, India. Microscopic image of retinoblastoma (hematoxylin and eosin stain, ×400 magnification) demonstrating characteristic rosette-like structures formed by tumor cells, including Flexner–Wintersteiner rosettes (with a central lumen), Homer–Wright rosettes (without a central lumen), and pseudorosettes (surrounding a central vascular space).
The Rosette Roadmap of Retinoblastoma by Poonam Arora Agrawal, Consultant Histopathologist, CentraPath labs, Indore, India. Microscopic image of retinoblastoma (hematoxylin and eosin stain, ×400 magnification) demonstrating characteristic rosette-like structures formed by tumor cells, including Flexner–Wintersteiner rosettes (with a central lumen), Homer–Wright rosettes (without a central lumen), and pseudorosettes (surrounding a central vascular space).
Nature’s Smear by Ragavi Vinuth, Consultant Pathologist, Neuberg diagnostics, Hosur, TamilNadu, India. A cytology smear where cell clusters resemble a bird. Microscopy imitates nature.
Nature’s Smear by Ragavi Vinuth, Consultant Pathologist, Neuberg diagnostics, Hosur, TamilNadu, India. A cytology smear where cell clusters resemble a bird. Microscopy imitates nature.
Signet by Ramya Chitturi, Assistant Professor of Pathology, Guntur Medical College, Guntur, India. A ring in the fluid "signet ring cell".
Signet by Ramya Chitturi, Assistant Professor of Pathology, Guntur Medical College, Guntur, India. A ring in the fluid "signet ring cell".
Pinkish Mangrove Forest by Rana Saleh, FRCpath, American Hospital Dubai, UAE. Colloid rich benign thyroid nodule.
Pinkish Mangrove Forest by Rana Saleh, FRCpath, American Hospital Dubai, UAE. Colloid rich benign thyroid nodule.
Aspergillus fruiting body H&E by Rana Saleh, FRCpath, American Hospital Dubai, UAE.
Aspergillus fruiting body H&E by Rana Saleh, FRCpath, American Hospital Dubai, UAE.
Is it Heartburn or Happy Belly! by Rohit Jain, Consultant Pathologist, Santokba Durlabhji Memorial Hospital, Jaipur, India, and Founding Secretary, Practicing Pathologists Society, Rajasthan, India. H&E stained gastric biopsy showing Heart shaped Gastric gland.
Is it Heartburn or Happy Belly! by Rohit Jain, Consultant Pathologist, Santokba Durlabhji Memorial Hospital, Jaipur, India, and Founding Secretary, Practicing Pathologists Society, Rajasthan, India. H&E stained gastric biopsy showing Heart shaped Gastric gland.
Malignant Colossus by Tania Labiano, Cytopathologist, Pamplona, Spain. This photomicrograph depicts an exceptionally large malignant cell from an EBUS-guided FNA cytology of lung adenocarcinoma.
Malignant Colossus by Tania Labiano, Cytopathologist, Pamplona, Spain. This photomicrograph depicts an exceptionally large malignant cell from an EBUS-guided FNA cytology of lung adenocarcinoma.
Gems by Ziad El-Zaatari, Houston Methodist Hospital, Houston, Texas USA. This image is a collage of corpora amylacea photographed during microscopic examination of prostates removed as treatment for prostate cancer. More than 150 corpora amylacea are shown, captured from at least 20 different prostates. They share recognizable features – lamellated (ring-like) layers, oval-round or polygonal shapes, and occasional fractures in tissue sections – yet no two look exactly alike, and their sizes vary widely. Their function is still debated, but they are generally thought to help collect and remove cellular waste. Importantly, corpora amylacea are a normal finding in benign prostate glands and are rarely seen in cancerous glands. Note: Images were taken at 4× to 40× magnification and digitally scaled so their relative sizes match how they would appear at 40×.
Gems by Ziad El-Zaatari, Houston Methodist Hospital, Houston, Texas USA. This image is a collage of corpora amylacea photographed during microscopic examination of prostates removed as treatment for prostate cancer. More than 150 corpora amylacea are shown, captured from at least 20 different prostates. They share recognizable features – lamellated (ring-like) layers, oval-round or polygonal shapes, and occasional fractures in tissue sections – yet no two look exactly alike, and their sizes vary widely. Their function is still debated, but they are generally thought to help collect and remove cellular waste. Importantly, corpora amylacea are a normal finding in benign prostate glands and are rarely seen in cancerous glands. Note: Images were taken at 4× to 40× magnification and digitally scaled so their relative sizes match how they would appear at 40×.
Green Glomerulus by Ziad El-Zaatari, Houston Methodist Hospital, Houston, Texas USA. During one case, we had problems with the usual Jones silver stain for renal tissue, so we used a GMS stain instead. The result is this striking green-stained glomerulus, since the GMS counterstain is green rather than the typical pink. The glomerulus – the tree- or mushroom-like structure – is centered in the image. The surrounding white area is the urinary space within Bowman’s capsule, and the renal cortical tubules line the periphery. This photo was taken with a smartphone through the microscope eyepiece, showing the full circular field of view.
Green Glomerulus by Ziad El-Zaatari, Houston Methodist Hospital, Houston, Texas USA. During one case, we had problems with the usual Jones silver stain for renal tissue, so we used a GMS stain instead. The result is this striking green-stained glomerulus, since the GMS counterstain is green rather than the typical pink. The glomerulus – the tree- or mushroom-like structure – is centered in the image. The surrounding white area is the urinary space within Bowman’s capsule, and the renal cortical tubules line the periphery. This photo was taken with a smartphone through the microscope eyepiece, showing the full circular field of view.
Colors of Colloid by Ziad El-Zaatari, Houston Methodist Hospital, Houston, Texas USA. This image shows the colorful patterns of colloid from thyroid fine-needle aspiration (FNA) samples. Mixed with blood and Papanicolaou stain, the colloid forms striking swirls, cracks, and varied textures. Abundant colloid in thyroid FNA samples is typically a reassuring sign that the biopsied nodule is benign – good news identified through the trained eye of a cytopathologist.
Colors of Colloid by Ziad El-Zaatari, Houston Methodist Hospital, Houston, Texas USA. This image shows the colorful patterns of colloid from thyroid fine-needle aspiration (FNA) samples. Mixed with blood and Papanicolaou stain, the colloid forms striking swirls, cracks, and varied textures. Abundant colloid in thyroid FNA samples is typically a reassuring sign that the biopsied nodule is benign – good news identified through the trained eye of a cytopathologist.
Mixed Media
Through the Enchanted Microscope by Ancy Jenil-Franco, Internal Medicine Resident at McLaren Bay Region, Michigan, USA. This is a glow-in-the-dark, 3D-printed book nook that I created using 3D prints, glow paint, and cardboard. Building it felt like stepping into a pathologist’s secret lair. Under the microscope, the world transforms into a hidden universe of pathophysiology – cells seem to whisper, disease patterns come alive, and everything takes on an almost poetic rhythm. At the microscope, the ordinary world fades away and science becomes art: a place where curiosity glows and comes alive under the lens.
Through the Enchanted Microscope by Ancy Jenil-Franco, Internal Medicine Resident at McLaren Bay Region, Michigan, USA. This is a glow-in-the-dark, 3D-printed book nook that I created using 3D prints, glow paint, and cardboard. Building it felt like stepping into a pathologist’s secret lair. Under the microscope, the world transforms into a hidden universe of pathophysiology – cells seem to whisper, disease patterns come alive, and everything takes on an almost poetic rhythm. At the microscope, the ordinary world fades away and science becomes art: a place where curiosity glows and comes alive under the lens.
Parasitic Attack by Anuradha Sujitkumar Pal, Second-year MBBS student, SMBT Institute of Medical Sciences and Research Centre, Nashik, India. Fresh vegetables are vital for health, but inadequate washing can turn them into a source of dangerous parasites. Vegetables grown in soil or irrigated with contaminated water may carry microscopic worm eggs that cling to leafy produce such as spinach, coriander, lettuce, and cabbage. When eaten raw or poorly cleaned, these eggs can cause intestinal infections leading to abdominal pain, diarrhea, anemia, and malnutrition, particularly affecting children’s growth and development. In some cases, parasites can spread beyond the intestine – for example, cysticercosis, in which pork tapeworm eggs form cysts in organs, including the brain, causing seizures and neurological complications. Simple food-safety practices such as thorough washing, soaking in salt water, good hand hygiene, and using clean water can prevent serious illness – just a few minutes of care can avert months of disease.
Parasitic Attack by Anuradha Sujitkumar Pal, Second-year MBBS student, SMBT Institute of Medical Sciences and Research Centre, Nashik, India. Fresh vegetables are vital for health, but inadequate washing can turn them into a source of dangerous parasites. Vegetables grown in soil or irrigated with contaminated water may carry microscopic worm eggs that cling to leafy produce such as spinach, coriander, lettuce, and cabbage. When eaten raw or poorly cleaned, these eggs can cause intestinal infections leading to abdominal pain, diarrhea, anemia, and malnutrition, particularly affecting children’s growth and development. In some cases, parasites can spread beyond the intestine – for example, cysticercosis, in which pork tapeworm eggs form cysts in organs, including the brain, causing seizures and neurological complications. Simple food-safety practices such as thorough washing, soaking in salt water, good hand hygiene, and using clean water can prevent serious illness – just a few minutes of care can avert months of disease.
Handled with Care by Cheyenne Martin, Second-Year Medical Student at Ponce Health Sciences University, St. Louis, Missouri, USA. Through dark imagery and unsettling dialogue, this poem personifies a pathogen in conversation with a food handler who has compromised food safety. It reveals how neglected sanitation allows contamination to flourish and harm future consumers. The work highlights the fragile boundary between routine behavior and public health risk, urging greater mindfulness in everyday food-handling practices.
Handled with Care by Cheyenne Martin, Second-Year Medical Student at Ponce Health Sciences University, St. Louis, Missouri, USA. Through dark imagery and unsettling dialogue, this poem personifies a pathogen in conversation with a food handler who has compromised food safety. It reveals how neglected sanitation allows contamination to flourish and harm future consumers. The work highlights the fragile boundary between routine behavior and public health risk, urging greater mindfulness in everyday food-handling practices.
Tissue is Still the Tissue by Daniel Miller, WashU Medicine, Department of Pathology & Immunology, Division of Anatomic and Molecular Pathology; Director, ENT Pathology Fellowship; Interim Section Head, ENT Pathology; Director, External Intraoperative Consultations. There once was a mass big and mean, But the biopsy sample was lean. The surgeons cried, “CIS?!” The onc sent NGS bliss, But tissue is still the issue, unseen.
Tissue is Still the Tissue by Daniel Miller, WashU Medicine, Department of Pathology & Immunology, Division of Anatomic and Molecular Pathology; Director, ENT Pathology Fellowship; Interim Section Head, ENT Pathology; Director, External Intraoperative Consultations. There once was a mass big and mean, But the biopsy sample was lean. The surgeons cried, “CIS?!” The onc sent NGS bliss, But tissue is still the issue, unseen.
Pushing [Stained] Glass by Emily Eischen Martin, fourth-year medical student at Rocky Vista University, Ivins, Utah, USA. Outside of the lab, one of my hobbies is creating stained glass art, including this iridescent stained glass microscope.
Pushing [Stained] Glass by Emily Eischen Martin, fourth-year medical student at Rocky Vista University, Ivins, Utah, USA. Outside of the lab, one of my hobbies is creating stained glass art, including this iridescent stained glass microscope.
Heart cake by Hollis H. Notgrass, Lead Pathologists' Assistant, Tissue Lab/Frozen Room Supervisor, UT Southwestern, Clements University Hospital, USA. I have been a self-taught cake decorator for more than 20 years, alongside a career in pathology that is nearly as long. One of the most meaningful moments of my life was creating the groom’s cake for one of my PA students, who proposed to the love of his life in our laboratory using a heart-shaped anatomical “ring box.” They later asked me to recreate that heart in cake form for their wedding, which I made as a red velvet cake covered in fondant. Other favorite creations for our pathologists and staff milestones include a placenta cake, a kidney cake, a “cuterus” cake for one of our HTs, a mandible cake topper made of fondant, and a farewell cake for a PA colleague complete with fondant “tools.” I love the intersection of my lifelong hobby and my career in pathology, and I would be delighted to be part of the PathArt project – although I’m not sure how well it fits under “food safety,” except to say these are the only pathology “specimens” I’d ever consider bringing to a party.
Heart cake by Hollis H. Notgrass, Lead Pathologists' Assistant, Tissue Lab/Frozen Room Supervisor, UT Southwestern, Clements University Hospital, USA. I have been a self-taught cake decorator for more than 20 years, alongside a career in pathology that is nearly as long. One of the most meaningful moments of my life was creating the groom’s cake for one of my PA students, who proposed to the love of his life in our laboratory using a heart-shaped anatomical “ring box.” They later asked me to recreate that heart in cake form for their wedding, which I made as a red velvet cake covered in fondant. Other favorite creations for our pathologists and staff milestones include a placenta cake, a kidney cake, a “cuterus” cake for one of our HTs, a mandible cake topper made of fondant, and a farewell cake for a PA colleague complete with fondant “tools.” I love the intersection of my lifelong hobby and my career in pathology, and I would be delighted to be part of the PathArt project – although I’m not sure how well it fits under “food safety,” except to say these are the only pathology “specimens” I’d ever consider bringing to a party.
Kidney cake by Hollis H. Notgrass, Lead Pathologists' Assistant, Tissue Lab/Frozen Room Supervisor, UT Southwestern, Clements University Hospital, USA. I have been a self-taught cake decorator for more than 20 years, alongside a career in pathology that is nearly as long. One of the most meaningful moments of my life was creating the groom’s cake for one of my PA students, who proposed to the love of his life in our laboratory using a heart-shaped anatomical “ring box.” They later asked me to recreate that heart in cake form for their wedding, which I made as a red velvet cake covered in fondant. Other favorite creations for our pathologists and staff milestones include a placenta cake, a kidney cake, a “cuterus” cake for one of our HTs, a mandible cake topper made of fondant, and a farewell cake for a PA colleague complete with fondant “tools.” I love the intersection of my lifelong hobby and my career in pathology, and I would be delighted to be part of the PathArt project – although I’m not sure how well it fits under “food safety,” except to say these are the only pathology “specimens” I’d ever consider bringing to a party.
Kidney cake by Hollis H. Notgrass, Lead Pathologists' Assistant, Tissue Lab/Frozen Room Supervisor, UT Southwestern, Clements University Hospital, USA. I have been a self-taught cake decorator for more than 20 years, alongside a career in pathology that is nearly as long. One of the most meaningful moments of my life was creating the groom’s cake for one of my PA students, who proposed to the love of his life in our laboratory using a heart-shaped anatomical “ring box.” They later asked me to recreate that heart in cake form for their wedding, which I made as a red velvet cake covered in fondant. Other favorite creations for our pathologists and staff milestones include a placenta cake, a kidney cake, a “cuterus” cake for one of our HTs, a mandible cake topper made of fondant, and a farewell cake for a PA colleague complete with fondant “tools.” I love the intersection of my lifelong hobby and my career in pathology, and I would be delighted to be part of the PathArt project – although I’m not sure how well it fits under “food safety,” except to say these are the only pathology “specimens” I’d ever consider bringing to a party.
Mandible cake by Hollis H. Notgrass, Lead Pathologists' Assistant, Tissue Lab/Frozen Room Supervisor, UT Southwestern, Clements University Hospital, USA. I have been a self-taught cake decorator for more than 20 years, alongside a career in pathology that is nearly as long. One of the most meaningful moments of my life was creating the groom’s cake for one of my PA students, who proposed to the love of his life in our laboratory using a heart-shaped anatomical “ring box.” They later asked me to recreate that heart in cake form for their wedding, which I made as a red velvet cake covered in fondant. Other favorite creations for our pathologists and staff milestones include a placenta cake, a kidney cake, a “cuterus” cake for one of our HTs, a mandible cake topper made of fondant, and a farewell cake for a PA colleague complete with fondant “tools.” I love the intersection of my lifelong hobby and my career in pathology, and I would be delighted to be part of the PathArt project – although I’m not sure how well it fits under “food safety,” except to say these are the only pathology “specimens” I’d ever consider bringing to a party.
Mandible cake by Hollis H. Notgrass, Lead Pathologists' Assistant, Tissue Lab/Frozen Room Supervisor, UT Southwestern, Clements University Hospital, USA. I have been a self-taught cake decorator for more than 20 years, alongside a career in pathology that is nearly as long. One of the most meaningful moments of my life was creating the groom’s cake for one of my PA students, who proposed to the love of his life in our laboratory using a heart-shaped anatomical “ring box.” They later asked me to recreate that heart in cake form for their wedding, which I made as a red velvet cake covered in fondant. Other favorite creations for our pathologists and staff milestones include a placenta cake, a kidney cake, a “cuterus” cake for one of our HTs, a mandible cake topper made of fondant, and a farewell cake for a PA colleague complete with fondant “tools.” I love the intersection of my lifelong hobby and my career in pathology, and I would be delighted to be part of the PathArt project – although I’m not sure how well it fits under “food safety,” except to say these are the only pathology “specimens” I’d ever consider bringing to a party.
Mandible topper by Hollis H. Notgrass, Lead Pathologists' Assistant, Tissue Lab/Frozen Room Supervisor, UT Southwestern, Clements University Hospital, USA. I have been a self-taught cake decorator for more than 20 years, alongside a career in pathology that is nearly as long. One of the most meaningful moments of my life was creating the groom’s cake for one of my PA students, who proposed to the love of his life in our laboratory using a heart-shaped anatomical “ring box.” They later asked me to recreate that heart in cake form for their wedding, which I made as a red velvet cake covered in fondant. Other favorite creations for our pathologists and staff milestones include a placenta cake, a kidney cake, a “cuterus” cake for one of our HTs, a mandible cake topper made of fondant, and a farewell cake for a PA colleague complete with fondant “tools.” I love the intersection of my lifelong hobby and my career in pathology, and I would be delighted to be part of the PathArt project – although I’m not sure how well it fits under “food safety,” except to say these are the only pathology “specimens” I’d ever consider bringing to a party.
Mandible topper by Hollis H. Notgrass, Lead Pathologists' Assistant, Tissue Lab/Frozen Room Supervisor, UT Southwestern, Clements University Hospital, USA. I have been a self-taught cake decorator for more than 20 years, alongside a career in pathology that is nearly as long. One of the most meaningful moments of my life was creating the groom’s cake for one of my PA students, who proposed to the love of his life in our laboratory using a heart-shaped anatomical “ring box.” They later asked me to recreate that heart in cake form for their wedding, which I made as a red velvet cake covered in fondant. Other favorite creations for our pathologists and staff milestones include a placenta cake, a kidney cake, a “cuterus” cake for one of our HTs, a mandible cake topper made of fondant, and a farewell cake for a PA colleague complete with fondant “tools.” I love the intersection of my lifelong hobby and my career in pathology, and I would be delighted to be part of the PathArt project – although I’m not sure how well it fits under “food safety,” except to say these are the only pathology “specimens” I’d ever consider bringing to a party.
PA cake by Hollis H. Notgrass, Lead Pathologists' Assistant, Tissue Lab/Frozen Room Supervisor, UT Southwestern, Clements University Hospital, USA. I have been a self-taught cake decorator for more than 20 years, alongside a career in pathology that is nearly as long. One of the most meaningful moments of my life was creating the groom’s cake for one of my PA students, who proposed to the love of his life in our laboratory using a heart-shaped anatomical “ring box.” They later asked me to recreate that heart in cake form for their wedding, which I made as a red velvet cake covered in fondant. Other favorite creations for our pathologists and staff milestones include a placenta cake, a kidney cake, a “cuterus” cake for one of our HTs, a mandible cake topper made of fondant, and a farewell cake for a PA colleague complete with fondant “tools.” I love the intersection of my lifelong hobby and my career in pathology, and I would be delighted to be part of the PathArt project – although I’m not sure how well it fits under “food safety,” except to say these are the only pathology “specimens” I’d ever consider bringing to a party.
PA cake by Hollis H. Notgrass, Lead Pathologists' Assistant, Tissue Lab/Frozen Room Supervisor, UT Southwestern, Clements University Hospital, USA. I have been a self-taught cake decorator for more than 20 years, alongside a career in pathology that is nearly as long. One of the most meaningful moments of my life was creating the groom’s cake for one of my PA students, who proposed to the love of his life in our laboratory using a heart-shaped anatomical “ring box.” They later asked me to recreate that heart in cake form for their wedding, which I made as a red velvet cake covered in fondant. Other favorite creations for our pathologists and staff milestones include a placenta cake, a kidney cake, a “cuterus” cake for one of our HTs, a mandible cake topper made of fondant, and a farewell cake for a PA colleague complete with fondant “tools.” I love the intersection of my lifelong hobby and my career in pathology, and I would be delighted to be part of the PathArt project – although I’m not sure how well it fits under “food safety,” except to say these are the only pathology “specimens” I’d ever consider bringing to a party.
Placenta cake by Hollis H. Notgrass, Lead Pathologists' Assistant, Tissue Lab/Frozen Room Supervisor, UT Southwestern, Clements University Hospital, USA. I have been a self-taught cake decorator for more than 20 years, alongside a career in pathology that is nearly as long. One of the most meaningful moments of my life was creating the groom’s cake for one of my PA students, who proposed to the love of his life in our laboratory using a heart-shaped anatomical “ring box.” They later asked me to recreate that heart in cake form for their wedding, which I made as a red velvet cake covered in fondant. Other favorite creations for our pathologists and staff milestones include a placenta cake, a kidney cake, a “cuterus” cake for one of our HTs, a mandible cake topper made of fondant, and a farewell cake for a PA colleague complete with fondant “tools.” I love the intersection of my lifelong hobby and my career in pathology, and I would be delighted to be part of the PathArt project – although I’m not sure how well it fits under “food safety,” except to say these are the only pathology “specimens” I’d ever consider bringing to a party.
Placenta cake by Hollis H. Notgrass, Lead Pathologists' Assistant, Tissue Lab/Frozen Room Supervisor, UT Southwestern, Clements University Hospital, USA. I have been a self-taught cake decorator for more than 20 years, alongside a career in pathology that is nearly as long. One of the most meaningful moments of my life was creating the groom’s cake for one of my PA students, who proposed to the love of his life in our laboratory using a heart-shaped anatomical “ring box.” They later asked me to recreate that heart in cake form for their wedding, which I made as a red velvet cake covered in fondant. Other favorite creations for our pathologists and staff milestones include a placenta cake, a kidney cake, a “cuterus” cake for one of our HTs, a mandible cake topper made of fondant, and a farewell cake for a PA colleague complete with fondant “tools.” I love the intersection of my lifelong hobby and my career in pathology, and I would be delighted to be part of the PathArt project – although I’m not sure how well it fits under “food safety,” except to say these are the only pathology “specimens” I’d ever consider bringing to a party.
Placenta uncut cake by Hollis H. Notgrass, Lead Pathologists' Assistant, Tissue Lab/Frozen Room Supervisor, UT Southwestern, Clements University Hospital, USA. I have been a self-taught cake decorator for more than 20 years, alongside a career in pathology that is nearly as long. One of the most meaningful moments of my life was creating the groom’s cake for one of my PA students, who proposed to the love of his life in our laboratory using a heart-shaped anatomical “ring box.” They later asked me to recreate that heart in cake form for their wedding, which I made as a red velvet cake covered in fondant. Other favorite creations for our pathologists and staff milestones include a placenta cake, a kidney cake, a “cuterus” cake for one of our HTs, a mandible cake topper made of fondant, and a farewell cake for a PA colleague complete with fondant “tools.” I love the intersection of my lifelong hobby and my career in pathology, and I would be delighted to be part of the PathArt project – although I’m not sure how well it fits under “food safety,” except to say these are the only pathology “specimens” I’d ever consider bringing to a party.
Placenta uncut cake by Hollis H. Notgrass, Lead Pathologists' Assistant, Tissue Lab/Frozen Room Supervisor, UT Southwestern, Clements University Hospital, USA. I have been a self-taught cake decorator for more than 20 years, alongside a career in pathology that is nearly as long. One of the most meaningful moments of my life was creating the groom’s cake for one of my PA students, who proposed to the love of his life in our laboratory using a heart-shaped anatomical “ring box.” They later asked me to recreate that heart in cake form for their wedding, which I made as a red velvet cake covered in fondant. Other favorite creations for our pathologists and staff milestones include a placenta cake, a kidney cake, a “cuterus” cake for one of our HTs, a mandible cake topper made of fondant, and a farewell cake for a PA colleague complete with fondant “tools.” I love the intersection of my lifelong hobby and my career in pathology, and I would be delighted to be part of the PathArt project – although I’m not sure how well it fits under “food safety,” except to say these are the only pathology “specimens” I’d ever consider bringing to a party.
Nature’s Gallbladder by Jason Innerhofer, Pathologists’ Assistant, Pathology Associates of Albuquerque, Presbyterian Healthcare Services, Albuquerque, New Mexico, USA.
Nature’s Gallbladder by Jason Innerhofer, Pathologists’ Assistant, Pathology Associates of Albuquerque, Presbyterian Healthcare Services, Albuquerque, New Mexico, USA.
Kidney Tubules by Marianne Hamel, Forensic pathologist, Jersey Shore Forensics, Bethlehem, PA, USA. Nikki Johnson, Forensic photographer, New York City. PAS stain of kidney tubules, 400X, shot on an Olympus DP26 digital camera. Turned into a 36 x 36 inch silk scarf with contrast stitching by Contrado.com for Death Under Glass.
Kidney Tubules by Marianne Hamel, Forensic pathologist, Jersey Shore Forensics, Bethlehem, PA, USA. Nikki Johnson, Forensic photographer, New York City. PAS stain of kidney tubules, 400X, shot on an Olympus DP26 digital camera. Turned into a 36 x 36 inch silk scarf with contrast stitching by Contrado.com for Death Under Glass.
Kidney Tubules by Marianne Hamel, Forensic pathologist, Jersey Shore Forensics, Bethlehem, PA, USA. Nikki Johnson, Forensic photographer, New York City. PAS stain of kidney tubules, 400X, shot on an Olympus DP26 digital camera. Turned into a 36 x 36 inch silk scarf with contrast stitching by Contrado.com for Death Under Glass.
Kidney Tubules by Marianne Hamel, Forensic pathologist, Jersey Shore Forensics, Bethlehem, PA, USA. Nikki Johnson, Forensic photographer, New York City. PAS stain of kidney tubules, 400X, shot on an Olympus DP26 digital camera. Turned into a 36 x 36 inch silk scarf with contrast stitching by Contrado.com for Death Under Glass.
The Invisible Labor of Pathology in Ensuring Global Food Safety by Muhammad Bilal, Allama Iqbal Medical College, Pakistan. This work explores the intersection of culinary art and diagnostic science, drawing attention to the often-invisible labor of pathology in safeguarding global food safety. Framed in a neoclassical aesthetic, it traces the journey from macroscopic contamination to microscopic identification. The Proliferation (Top Left): A stylized depiction of enteric pathogens, including Salmonella and Listeria species. Interlocking patterns evoke the rapid colonization of contaminated surfaces. The Macroscopic Reality (Top Right): A hyper-realistic study of fungal spoilage on common grain-based substrates. Neon luminescence symbolizes hidden dangers – mycotoxins invisible to the naked eye but rendered here as a visual warning. The Chemical Signature (Bottom Left): Referencing polarized light microscopy (PLM), this panel captures the crystalline geometry of foodborne toxins and chemical preservatives, revealing order within apparent chaos. The Diagnostic Icon (Bottom Right): Using a bioluminescent motif, kitchen tools – a chef’s toque and cutlery – are transformed into a glowing bacterial culture, representing the pathologist’s role in identifying threats to protect the table.
The Invisible Labor of Pathology in Ensuring Global Food Safety by Muhammad Bilal, Allama Iqbal Medical College, Pakistan. This work explores the intersection of culinary art and diagnostic science, drawing attention to the often-invisible labor of pathology in safeguarding global food safety. Framed in a neoclassical aesthetic, it traces the journey from macroscopic contamination to microscopic identification. The Proliferation (Top Left): A stylized depiction of enteric pathogens, including Salmonella and Listeria species. Interlocking patterns evoke the rapid colonization of contaminated surfaces. The Macroscopic Reality (Top Right): A hyper-realistic study of fungal spoilage on common grain-based substrates. Neon luminescence symbolizes hidden dangers – mycotoxins invisible to the naked eye but rendered here as a visual warning. The Chemical Signature (Bottom Left): Referencing polarized light microscopy (PLM), this panel captures the crystalline geometry of foodborne toxins and chemical preservatives, revealing order within apparent chaos. The Diagnostic Icon (Bottom Right): Using a bioluminescent motif, kitchen tools – a chef’s toque and cutlery – are transformed into a glowing bacterial culture, representing the pathologist’s role in identifying threats to protect the table.
3D Urothelium by Nicolò Vianini, 3rd year Pathology Resident, University of Verona – Hospital Trust, Italy. This is a 3D urothelium painting of bladder mucosa. The urothelium is the left part of the image, with purple and blue parts. In particular, the umbrella cells are purple and pink, while urothelial cells are blue with black nuclei. The urine is light blue, with bubbles in grey.
3D Urothelium by Nicolò Vianini, 3rd year Pathology Resident, University of Verona – Hospital Trust, Italy. This is a 3D urothelium painting of bladder mucosa. The urothelium is the left part of the image, with purple and blue parts. In particular, the umbrella cells are purple and pink, while urothelial cells are blue with black nuclei. The urine is light blue, with bubbles in grey.
When Passion Meets Profession by Ramyashree G, Assistant Professor, Department of Pathology, S.S Institute of Medical Sciences, Davangere, Karnataka, India. This microscope was created using dot mandal.
When Passion Meets Profession by Ramyashree G, Assistant Professor, Department of Pathology, S.S Institute of Medical Sciences, Davangere, Karnataka, India. This microscope was created using dot mandal.
The Shiga Toxin Tale by Smitirupa Mishra, Consultant Pathologist, Sparsh Hospital, Bhubaneswar, India. This is my creative food safety-themed poem that vividly explains E. coli O157:H7-induced hemolytic uremic syndrome, tracing the journey of Shiga toxin from gut infection to microangiopathic hemolysis, thrombocytopenia, and acute kidney injury in a memorable, educational rhyme.
The Shiga Toxin Tale by Smitirupa Mishra, Consultant Pathologist, Sparsh Hospital, Bhubaneswar, India. This is my creative food safety-themed poem that vividly explains E. coli O157:H7-induced hemolytic uremic syndrome, tracing the journey of Shiga toxin from gut infection to microangiopathic hemolysis, thrombocytopenia, and acute kidney injury in a memorable, educational rhyme.
ESCMID Global Partnership / Food Safety
Angel of Peace by Aleksandra Jovanović, Specialist in Medical Microbiology, General Hospital Valjevo, Belgrade, and Institute for Laboratory Diagnostics Biomedica, Belgrade, Serbia. Perched on a pedestal, the Angel of Peace (Friedensengel) overlooks the city. Created on XLD medium from Salmonella Enteritidis, Klebsiella pneumoniae, Proteus mirabilis, and Pseudomonas aeruginosa, it represents bacteria that can contaminate food and threaten health. Just as the angel guards the city, food safety protects consumers from unseen risks.
Angel of Peace by Aleksandra Jovanović, Specialist in Medical Microbiology, General Hospital Valjevo, Belgrade, and Institute for Laboratory Diagnostics Biomedica, Belgrade, Serbia. Perched on a pedestal, the Angel of Peace (Friedensengel) overlooks the city. Created on XLD medium from Salmonella Enteritidis, Klebsiella pneumoniae, Proteus mirabilis, and Pseudomonas aeruginosa, it represents bacteria that can contaminate food and threaten health. Just as the angel guards the city, food safety protects consumers from unseen risks.
I Will Never Forget You by Aleksandra Jovanović, Specialist in Medical Microbiology, General Hospital Valjevo, Belgrade, and Institute for Laboratory Diagnostics Biomedica, Belgrade, Serbia. On this delicate agar, science meets emotion as microorganisms become faces and food becomes memory. Escherichia coli, Klebsiella spp, Staphylococcus saprophyticus, Candida albicans, Candida tropicalis, and Candida glabrata remind us that trust without care can cause harm. Food safety is an act of protection – for health, for life, and for those we safeguard.
I Will Never Forget You by Aleksandra Jovanović, Specialist in Medical Microbiology, General Hospital Valjevo, Belgrade, and Institute for Laboratory Diagnostics Biomedica, Belgrade, Serbia. On this delicate agar, science meets emotion as microorganisms become faces and food becomes memory. Escherichia coli, Klebsiella spp, Staphylococcus saprophyticus, Candida albicans, Candida tropicalis, and Candida glabrata remind us that trust without care can cause harm. Food safety is an act of protection – for health, for life, and for those we safeguard.
My Food is Contaminated by Toxins by Alex Zapata, MSc in Biomedicine, Mycology and Tuberculosis Unit, Hospital de Especialidades Carlos Andrade Marín, and Faculty of Health Sciences, Universidad Internacional SEK, Quito, Ecuador. Mycotoxins are toxic compounds produced by fungi that contaminate food, threatening food safety, causing economic losses, and leading to acute and chronic health effects. What may be hidden in your food?
My Food is Contaminated by Toxins by Alex Zapata, MSc in Biomedicine, Mycology and Tuberculosis Unit, Hospital de Especialidades Carlos Andrade Marín, and Faculty of Health Sciences, Universidad Internacional SEK, Quito, Ecuador. Mycotoxins are toxic compounds produced by fungi that contaminate food, threatening food safety, causing economic losses, and leading to acute and chronic health effects. What may be hidden in your food?
A Tribute to Serendipity: Fleming’s Bread by Alexandru Botan, Cluj-Napoca, Romania. For the “Food Safety” theme, this piece reflects the paradox of spoilage that saved millions. Depicting the accidental discovery of penicillin, it uses the biochemical reactions of UTI agar as a natural palette: Proteus mirabilis forms the toasted brown crust, Enterococcus faecium the turquoise “mold,” and Candida albicans the soft white dough. It captures the moment a biological hazard became a medical breakthrough.
A Tribute to Serendipity: Fleming’s Bread by Alexandru Botan, Cluj-Napoca, Romania. For the “Food Safety” theme, this piece reflects the paradox of spoilage that saved millions. Depicting the accidental discovery of penicillin, it uses the biochemical reactions of UTI agar as a natural palette: Proteus mirabilis forms the toasted brown crust, Enterococcus faecium the turquoise “mold,” and Candida albicans the soft white dough. It captures the moment a biological hazard became a medical breakthrough.
Famished Workers Harvesting Sick Corn During Sunrise by Aliosha Feuss, Paris, France. The image shows crop workers harvesting corn at sunrise – overworked and hungry – while much of the crop is blighted with Fusarium and only a few plants remain untouched. Interpreting “Food Safety” as the security of feeding all, the piece reflects how fungal resistance and climate change threaten that stability. Created from an original Midjourney prompt, it draws viewers in with warm sunrise tones before revealing a darker undercurrent of unease.
Famished Workers Harvesting Sick Corn During Sunrise by Aliosha Feuss, Paris, France. The image shows crop workers harvesting corn at sunrise – overworked and hungry – while much of the crop is blighted with Fusarium and only a few plants remain untouched. Interpreting “Food Safety” as the security of feeding all, the piece reflects how fungal resistance and climate change threaten that stability. Created from an original Midjourney prompt, it draws viewers in with warm sunrise tones before revealing a darker undercurrent of unease.
Ash Drawing: Claviceps (Ergot) by Anna Dumitriu, Artist in Residence, The Magan Centre for Applied Mycology, University of Cranfield, Brighton, UK. This drawing was created using charcoal made from incinerated ergot and a putty rubber. Ergot is a mold that infects cereal grains such as rye, wheat, and barley, forming hard, dark toxic structures called sclerotia that can contaminate food without rigorous testing. Ingesting ergot can cause ergotism, a potentially fatal poisoning marked by hallucinations, spasms, gangrene, and death, and historically linked to outbreaks such as the Salem witch trials. Rising temperatures and increased carbon dioxide levels may also boost mold growth and the production of dangerous mycotoxins in food.
Ash Drawing: Claviceps (Ergot) by Anna Dumitriu, Artist in Residence, The Magan Centre for Applied Mycology, University of Cranfield, Brighton, UK. This drawing was created using charcoal made from incinerated ergot and a putty rubber. Ergot is a mold that infects cereal grains such as rye, wheat, and barley, forming hard, dark toxic structures called sclerotia that can contaminate food without rigorous testing. Ingesting ergot can cause ergotism, a potentially fatal poisoning marked by hallucinations, spasms, gangrene, and death, and historically linked to outbreaks such as the Salem witch trials. Rising temperatures and increased carbon dioxide levels may also boost mold growth and the production of dangerous mycotoxins in food.
Invisible threat: Listeria and Food Safety by Anne-Marie Dolan, Clinical Microbiology Spr, Department of Clinical Microbiology, Beaumont Hospital, Dublin, Ireland, Saoirse Ni Bhaoill, Clinical Microbiology Spr, Department of Clinical Microbiology, Beaumont Hospital, Dublin, Ireland, Jane O'Connor, Clinical Microbiology Spr, Department of Clinical Microbiology, Beaumont Hospital, Dublin, Ireland, Martha Glynn, Clinical Microbiology Spr, Department of Clinical Microbiology, Beaumont Hospital, Dublin, Ireland, John Oscar Gibbons, Clinical Microbiology SHO, Department of Clinical Microbiology, Beaumont Hospital, Dublin, Ireland and Saied Ali, Clinical Microbiology Spr, Department of Clinical Microbiology, Beaumont Hospital, and Department of Clinical Microbiology, Royal College of Surgeons in Ireland, Dublin, Ireland. This photograph examines food safety through the lens of a 2025 Listeria outbreak in Ireland. A pregnant woman and her child stand before an open refrigerator, a domestic space turned site of risk, with food overlaid by magnified Listeria monocytogenes. The image underscores vulnerability – especially during pregnancy – and the invisible pathways of contamination in daily life. By pairing family intimacy with microbial threat, it calls for vigilance, responsibility, and trust in public health systems to protect future generations.
Invisible threat: Listeria and Food Safety by Anne-Marie Dolan, Clinical Microbiology Spr, Department of Clinical Microbiology, Beaumont Hospital, Dublin, Ireland, Saoirse Ni Bhaoill, Clinical Microbiology Spr, Department of Clinical Microbiology, Beaumont Hospital, Dublin, Ireland, Jane O'Connor, Clinical Microbiology Spr, Department of Clinical Microbiology, Beaumont Hospital, Dublin, Ireland, Martha Glynn, Clinical Microbiology Spr, Department of Clinical Microbiology, Beaumont Hospital, Dublin, Ireland, John Oscar Gibbons, Clinical Microbiology SHO, Department of Clinical Microbiology, Beaumont Hospital, Dublin, Ireland and Saied Ali, Clinical Microbiology Spr, Department of Clinical Microbiology, Beaumont Hospital, and Department of Clinical Microbiology, Royal College of Surgeons in Ireland, Dublin, Ireland. This photograph examines food safety through the lens of a 2025 Listeria outbreak in Ireland. A pregnant woman and her child stand before an open refrigerator, a domestic space turned site of risk, with food overlaid by magnified Listeria monocytogenes. The image underscores vulnerability – especially during pregnancy – and the invisible pathways of contamination in daily life. By pairing family intimacy with microbial threat, it calls for vigilance, responsibility, and trust in public health systems to protect future generations.
A Forgotten Parasite in Chronic Diarrhea by Bishal Gupta, DM Virology Senior Resident, Virology Section under Department of Microbiology, All India Institute of Medical Sciences (AIIMS), Bhopal, India. A 67-year-old man with chronic alcohol use presented with one month of recurrent diarrhea and weight loss. Wet mount preparation and Kinyoun stain identified Cystoisospora belli oocysts. He was treated with double-strength cotrimoxazole twice daily for seven days.
A Forgotten Parasite in Chronic Diarrhea by Bishal Gupta, DM Virology Senior Resident, Virology Section under Department of Microbiology, All India Institute of Medical Sciences (AIIMS), Bhopal, India. A 67-year-old man with chronic alcohol use presented with one month of recurrent diarrhea and weight loss. Wet mount preparation and Kinyoun stain identified Cystoisospora belli oocysts. He was treated with double-strength cotrimoxazole twice daily for seven days.
A Cultured Dinner by Carmen Palacios Clar, Clinical microbiologist, Hospital Universitario Nuestra Señora de Candelaria, Santa Cruz Tenerife, Spain. This piece contrasts the familiarity of a plated chicken with its unseen microbiological reality. By transforming the meal into a living agar culture, it merges laboratory imagery with everyday dining and invites viewers to look more closely at what is often taken for granted.
A Cultured Dinner by Carmen Palacios Clar, Clinical microbiologist, Hospital Universitario Nuestra Señora de Candelaria, Santa Cruz Tenerife, Spain. This piece contrasts the familiarity of a plated chicken with its unseen microbiological reality. By transforming the meal into a living agar culture, it merges laboratory imagery with everyday dining and invites viewers to look more closely at what is often taken for granted.
Food Safety, One Drop at a Time by Clara Jensen, Sales Assistant, SSI Diagnostica, Hillerød, Denmark. This drawing depicts slide agglutination serotyping, a key tool in food safety microbiology. A drop of antisera is mixed with a bacterial colony on a glass slide, producing visible agglutination in positive results (left) and none in negative results (right). By distinguishing strains relevant to food safety, the method supports outbreak detection and prevention – showing how a single drop on a slide can shape decisions beyond the laboratory.
Food Safety, One Drop at a Time by Clara Jensen, Sales Assistant, SSI Diagnostica, Hillerød, Denmark. This drawing depicts slide agglutination serotyping, a key tool in food safety microbiology. A drop of antisera is mixed with a bacterial colony on a glass slide, producing visible agglutination in positive results (left) and none in negative results (right). By distinguishing strains relevant to food safety, the method supports outbreak detection and prevention – showing how a single drop on a slide can shape decisions beyond the laboratory.
Food’s Hidden Duality: Safety and Microbial Threats by Claudia Rotondo, Rome, Italy. This artwork reimagines Arcimboldo’s style in two contrasting halves, highlighting the fragile boundary between safety and contamination – a core principle of food microbiology. Inspired by daily laboratory work, it reflects how the unseen microbial world continually challenges food safety.
Food’s Hidden Duality: Safety and Microbial Threats by Claudia Rotondo, Rome, Italy. This artwork reimagines Arcimboldo’s style in two contrasting halves, highlighting the fragile boundary between safety and contamination – a core principle of food microbiology. Inspired by daily laboratory work, it reflects how the unseen microbial world continually challenges food safety.
Everyday Food, Invisible Risk: Food Safety on Selective Media by Dana Ciausu-Sliwa, PhD student and research assistant at “Ion Ionescu de la Brad” University of Life Sciences, Iași, Romania. This series offers a microbiological interpretation of food safety using selective and chromogenic culture media. Familiar foods – egg, fermented cheese, citrus fruit, and sushi – are recreated with bacteria linked to foodborne transmission and hygiene control. Color changes and colony morphology reflect metabolic reactions within each medium, serving as diagnostic indicators rather than artistic effects. The work highlights how everyday foods and routine handling practices can carry risk. For biosafety, all plates were permanently sealed with epoxy resin after incubation.
Everyday Food, Invisible Risk: Food Safety on Selective Media by Dana Ciausu-Sliwa, PhD student and research assistant at “Ion Ionescu de la Brad” University of Life Sciences, Iași, Romania. This series offers a microbiological interpretation of food safety using selective and chromogenic culture media. Familiar foods – egg, fermented cheese, citrus fruit, and sushi – are recreated with bacteria linked to foodborne transmission and hygiene control. Color changes and colony morphology reflect metabolic reactions within each medium, serving as diagnostic indicators rather than artistic effects. The work highlights how everyday foods and routine handling practices can carry risk. For biosafety, all plates were permanently sealed with epoxy resin after incubation.
Fresh Fish at the Foot of the Andes by Dennys Chicaiza, First Year Medical Resident in Microbiology and Parasitology, Hospital Universitario Nuestra Señora de Candelaria, Santa Cruz Tenerife, Spain. There's nothing better than eating fresh food at the foot of the volcano. From the safety of the Andes, under the eternal snow of Cotopaxi.
Fresh Fish at the Foot of the Andes by Dennys Chicaiza, First Year Medical Resident in Microbiology and Parasitology, Hospital Universitario Nuestra Señora de Candelaria, Santa Cruz Tenerife, Spain. There's nothing better than eating fresh food at the foot of the volcano. From the safety of the Andes, under the eternal snow of Cotopaxi.
Guardians of Food Safety by Eren Öztürk, TAE National Representative for Infectious Diseases (Türkiye) and Steering Committee Member, Department of Infectious Diseases and Clinical Microbiology, Ankara University Faculty of Medicine, Ankara, Turkey. A laboratory scientist carefully examines a culture plate, symbolising the critical role of science in ensuring food safety. The vivid colours reflect the hidden microbial world within food, highlighting vigilance, precision, and responsibility in protecting public health from foodborne risks.
Guardians of Food Safety by Eren Öztürk, TAE National Representative for Infectious Diseases (Türkiye) and Steering Committee Member, Department of Infectious Diseases and Clinical Microbiology, Ankara University Faculty of Medicine, Ankara, Turkey. A laboratory scientist carefully examines a culture plate, symbolising the critical role of science in ensuring food safety. The vivid colours reflect the hidden microbial world within food, highlighting vigilance, precision, and responsibility in protecting public health from foodborne risks.
Feedback by Ezgi Belil Durmus, Specialist in Infectious Diseases and Clinical Microbiology, Istanbul Faculty of Medicine, Istanbul University, Istanbul, Turkey. This artwork features Pseudomonas aeruginosa, Klebsiella pneumoniae, Staphylococcus aureus, coagulase-negative staphylococci, Enterococcus faecalis, and Escherichia coli. It illustrates how low-dose antibiotics once used as growth promoters in poultry created selective pressure in the gut microbiota, driving antimicrobial resistance. The spread of resistant pathogens ultimately threatens food safety.
Feedback by Ezgi Belil Durmus, Specialist in Infectious Diseases and Clinical Microbiology, Istanbul Faculty of Medicine, Istanbul University, Istanbul, Turkey. This artwork features Pseudomonas aeruginosa, Klebsiella pneumoniae, Staphylococcus aureus, coagulase-negative staphylococci, Enterococcus faecalis, and Escherichia coli. It illustrates how low-dose antibiotics once used as growth promoters in poultry created selective pressure in the gut microbiota, driving antimicrobial resistance. The spread of resistant pathogens ultimately threatens food safety.
The Journey of a Meal by Fahmeeda Idrees, Researcher, Tampere University, Finland. The Journey of a Meal explores how food travels from source to table, and how unseen microbes travel with it. Through simple, relatable language, it reflects on hygiene, contamination, and prevention. Drawing on my work in public health, the poem highlights how small everyday actions protect communities. I hope it encourages readers to see food safety as both personal responsibility and shared care.
The Journey of a Meal by Fahmeeda Idrees, Researcher, Tampere University, Finland. The Journey of a Meal explores how food travels from source to table, and how unseen microbes travel with it. Through simple, relatable language, it reflects on hygiene, contamination, and prevention. Drawing on my work in public health, the poem highlights how small everyday actions protect communities. I hope it encourages readers to see food safety as both personal responsibility and shared care.
The Last Supper by Fatima Dakroub, Research Associate, American University of Beirut, Hamra, Lebanon. This painting invites us to look more closely at what we eat. Hidden among the food are unseen threats – Aspergillus colonizing bread and tapeworms in raw fish. At its center, an hourglass filled with consequences suggests that what seems harmless at consumption may carry delayed, sometimes serious effects. The Last Supper is not about fear, but awareness – questioning how much trust we place in what we cannot see.
The Last Supper by Fatima Dakroub, Research Associate, American University of Beirut, Hamra, Lebanon. This painting invites us to look more closely at what we eat. Hidden among the food are unseen threats – Aspergillus colonizing bread and tapeworms in raw fish. At its center, an hourglass filled with consequences suggests that what seems harmless at consumption may carry delayed, sometimes serious effects. The Last Supper is not about fear, but awareness – questioning how much trust we place in what we cannot see.
Safer at Home When Handled with Care, Safe Outside Only with Reliable Source by Fatma Erdem, Associate Professor, Department of Medical Microbiology, Eskişehir Osmangazi University Faculty of Medicine, Eskişehi, Turkey. This agar art explores food safety as a practice grounded in care and trust. By contrasting the home kitchen with its invisible microbial world, it suggests that safety depends on careful handling at home and reliable sources beyond it. The piece reframes food safety not as the absence of microbes, but as the result of informed attention.
Safer at Home When Handled with Care, Safe Outside Only with Reliable Source by Fatma Erdem, Associate Professor, Department of Medical Microbiology, Eskişehir Osmangazi University Faculty of Medicine, Eskişehi, Turkey. This agar art explores food safety as a practice grounded in care and trust. By contrasting the home kitchen with its invisible microbial world, it suggests that safety depends on careful handling at home and reliable sources beyond it. The piece reframes food safety not as the absence of microbes, but as the result of informed attention.
The Illusion of Innocence by Hanadi Hajrulahović, Student, Richmond Park College, Bihać, Bosnia & Herzegovina. Controlling environmental microorganisms is essential to food safety, requiring protection of beneficial species and management of harmful ones. Escherichia coli and Staphylococcus aureus form these striking grapes – visually appealing, yet far from harmless as food contaminants.
The Illusion of Innocence by Hanadi Hajrulahović, Student, Richmond Park College, Bihać, Bosnia & Herzegovina. Controlling environmental microorganisms is essential to food safety, requiring protection of beneficial species and management of harmful ones. Escherichia coli and Staphylococcus aureus form these striking grapes – visually appealing, yet far from harmless as food contaminants.
Food Choice, Microbial Consequence: Aquaculture and Food Safety on Chromogenic Media by Iacob Ana Maria, “Ion Ionescu de la Brad” University of Life Sciences, Iași, Romania. This work presents a microbiological view of food safety at the aquaculture–consumer interface using chromogenic media. A carp, recreated on UriSelect agar, forms a polymicrobial landscape reflecting contamination, handling, and animal health. Bacterial and yeast isolates were pre-identified by MALDI-TOF MS (Zybio) and selected for characteristic chromogenic reactions and pigment expression. Rather than highlighting a single pathogen, the image shows how risks arise from multiple microbial actors. For biosafety and preservation, the plate was permanently sealed with epoxy resin after incubation.
Food Choice, Microbial Consequence: Aquaculture and Food Safety on Chromogenic Media by Iacob Ana Maria, “Ion Ionescu de la Brad” University of Life Sciences, Iași, Romania. This work presents a microbiological view of food safety at the aquaculture–consumer interface using chromogenic media. A carp, recreated on UriSelect agar, forms a polymicrobial landscape reflecting contamination, handling, and animal health. Bacterial and yeast isolates were pre-identified by MALDI-TOF MS (Zybio) and selected for characteristic chromogenic reactions and pigment expression. Rather than highlighting a single pathogen, the image shows how risks arise from multiple microbial actors. For biosafety and preservation, the plate was permanently sealed with epoxy resin after incubation.
Apple Washing by Jesús García-Martínez and Silvia Caamaño García, [job titles/affiliations], Fuenlabrada, Spain. A work that blends food safety and plate culture. It is inspired by the need to wash fresh fruit.
Apple Washing by Jesús García-Martínez and Silvia Caamaño García, [job titles/affiliations], Fuenlabrada, Spain. A work that blends food safety and plate culture. It is inspired by the need to wash fresh fruit.
Food Safety Scheme by Karolina Dydak, Wrocław, Poland. This image is inspired by the FDA’s safe food handling guidance: Clean – wash hands and surfaces often; Separate – keep raw meats apart from other foods; Cook – to the correct temperature; and Chill – refrigerate promptly. It was created on tryptone soya agar using Micrococcus luteus (yellow), Pseudomonas aeruginosa (brown and green), Staphylococcus equorum (white), and Microbacterium hydrocarbonoxydans (orange).
Food Safety Scheme by Karolina Dydak, Wrocław, Poland. This image is inspired by the FDA’s safe food handling guidance: Clean – wash hands and surfaces often; Separate – keep raw meats apart from other foods; Cook – to the correct temperature; and Chill – refrigerate promptly. It was created on tryptone soya agar using Micrococcus luteus (yellow), Pseudomonas aeruginosa (brown and green), Staphylococcus equorum (white), and Microbacterium hydrocarbonoxydans (orange).
More than Meets the Eye... by Katarzyna Kania, Research and Teaching Assistant, Department of Pharmaceutical Microbiology, Faculty of Pharmacy, Jagiellonian University Medical College, and Clinical Laboratory Diagnostician and Specialist in Medical Microbiology, Laboratory of Microbiology, St. John Paul II Specialist Hospital, Krakow, Poland. This work depicts selected Aspergillus species (A. fischeri, A. fumigatus, A. flavus, and A. niger) as a visual metaphor for food safety challenges across diverse products. Dried and long-stored foods can contain stable mycotoxins – including aflatoxins, ochratoxin A, sterigmatocystin, and cyclopiazonic acid – even without visible contamination, as these compounds persist despite processing methods such as drying or smoking. The image underscores the hidden risks within food diversity and the need for vigilant monitoring and control.
More than Meets the Eye... by Katarzyna Kania, Research and Teaching Assistant, Department of Pharmaceutical Microbiology, Faculty of Pharmacy, Jagiellonian University Medical College, and Clinical Laboratory Diagnostician and Specialist in Medical Microbiology, Laboratory of Microbiology, St. John Paul II Specialist Hospital, Krakow, Poland. This work depicts selected Aspergillus species (A. fischeri, A. fumigatus, A. flavus, and A. niger) as a visual metaphor for food safety challenges across diverse products. Dried and long-stored foods can contain stable mycotoxins – including aflatoxins, ochratoxin A, sterigmatocystin, and cyclopiazonic acid – even without visible contamination, as these compounds persist despite processing methods such as drying or smoking. The image underscores the hidden risks within food diversity and the need for vigilant monitoring and control.
Deadly Harvest by Katherine Watson, Microbiology Consultant,South Tyneside and Sunderland NHS Foundation Trust, Newcastle Upon Tyne, UK. This sculpture, made from crochet and modelling clay, highlights rising antifungal resistance in Aspergillus strains linked to widespread azole fungicide use in agriculture. A 2025 report from five EU health and environmental agencies calls for cross-sector collaboration to address this growing public health threat.
Deadly Harvest by Katherine Watson, Microbiology Consultant,South Tyneside and Sunderland NHS Foundation Trust, Newcastle Upon Tyne, UK. This sculpture, made from crochet and modelling clay, highlights rising antifungal resistance in Aspergillus strains linked to widespread azole fungicide use in agriculture. A 2025 report from five EU health and environmental agencies calls for cross-sector collaboration to address this growing public health threat.
A Fluorescent Warning by Laura Cabrera Martín, Third Year Medical Resident in Microbiology and Parasitology, Hospital Universitario Nuestra Señora de Candelaria, Santa Cruz Tenerife, Spain. Under fluorescence microscopy, Cryptosporidium oocysts appear as bright green signals after auramine staining. Invisible to the naked eye, these food- and waterborne parasites remain a persistent threat to food safety and public health.
A Fluorescent Warning by Laura Cabrera Martín, Third Year Medical Resident in Microbiology and Parasitology, Hospital Universitario Nuestra Señora de Candelaria, Santa Cruz Tenerife, Spain. Under fluorescence microscopy, Cryptosporidium oocysts appear as bright green signals after auramine staining. Invisible to the naked eye, these food- and waterborne parasites remain a persistent threat to food safety and public health.
The Sentinel’s View: Bridging the Farm-to-Fork Frontier by Lohithalinkam Logica, MD Trainee in Medical Microbiology, Post Graduate Institute of Medicine (PGIM), Colombo, Sri Lanka. This agar art depicts the farm-to-fork continuum, with a bird as a natural sentinel at the boundary between the wild and agricultural production. The invisible Escherichia coli embedded in the chromogenic agar highlights the need to identify microbial risks at their source before they reach the table. Food safety begins not in the kitchen, but in the field, where environmental monitoring serves as our first line of defense.
The Sentinel’s View: Bridging the Farm-to-Fork Frontier by Lohithalinkam Logica, MD Trainee in Medical Microbiology, Post Graduate Institute of Medicine (PGIM), Colombo, Sri Lanka. This agar art depicts the farm-to-fork continuum, with a bird as a natural sentinel at the boundary between the wild and agricultural production. The invisible Escherichia coli embedded in the chromogenic agar highlights the need to identify microbial risks at their source before they reach the table. Food safety begins not in the kitchen, but in the field, where environmental monitoring serves as our first line of defense.
Invisible Guardians of Food Safety by Mihaela Ioana, Timișoara, Romania. This agar art reimagines everyday food safety practices from a microbial perspective. Dirty hands, unsafe water, undercooked ingredients, and kitchen tools emerge from pigmented bacterial cultures, reflecting critical control points where human behavior intersects with microbial life. The work underscores the fine balance between contamination and prevention, emphasizing that food safety is a shared responsibility grounded in microbiological awareness.
Invisible Guardians of Food Safety by Mihaela Ioana, Timișoara, Romania. This agar art reimagines everyday food safety practices from a microbial perspective. Dirty hands, unsafe water, undercooked ingredients, and kitchen tools emerge from pigmented bacterial cultures, reflecting critical control points where human behavior intersects with microbial life. The work underscores the fine balance between contamination and prevention, emphasizing that food safety is a shared responsibility grounded in microbiological awareness.
Grapes Through a Microbiologist’s Eye by Selma Habibović, Specialist in Medical Microbiology, Institute of Public Health Novi Pazar, Serbia. Food safety depends on microorganisms, which quietly shape quality and hygiene. On HiMedia Blood Agar, Staphylococcus aureus, forming its typical grouped colonies, creates a grape-like shape – symbolizing fertility and fermentation. Beside it spreads a leaf formed by Pseudomonas aeruginosa, reflecting microbial flows during food processing and storage. The grape and leaf merge the aesthetics of produce with microbial risks and benefits. Inspired by European food culture, this work highlights the crucial role of microorganisms in food safety, reminding us that hygiene and quality begin long before food reaches the table.
Grapes Through a Microbiologist’s Eye by Selma Habibović, Specialist in Medical Microbiology, Institute of Public Health Novi Pazar, Serbia. Food safety depends on microorganisms, which quietly shape quality and hygiene. On HiMedia Blood Agar, Staphylococcus aureus, forming its typical grouped colonies, creates a grape-like shape – symbolizing fertility and fermentation. Beside it spreads a leaf formed by Pseudomonas aeruginosa, reflecting microbial flows during food processing and storage. The grape and leaf merge the aesthetics of produce with microbial risks and benefits. Inspired by European food culture, this work highlights the crucial role of microorganisms in food safety, reminding us that hygiene and quality begin long before food reaches the table.
The Last Supper by Shahzad Mirza, Professor, Department of Microbiology, Dr D Y Patil Medical College, Hospital and Research Centre, Pimpri, Pune, India. A microbial reimagining of a communal feast, exploring the tension between food as sustenance and as a potential vector of disease, with the “meal” constructed from the very biological agents that threaten global food safety.
The Last Supper by Shahzad Mirza, Professor, Department of Microbiology, Dr D Y Patil Medical College, Hospital and Research Centre, Pimpri, Pune, India. A microbial reimagining of a communal feast, exploring the tension between food as sustenance and as a potential vector of disease, with the “meal” constructed from the very biological agents that threaten global food safety.
They’re Everywhere by Shelley Peterson, A/Head STI Unit, National Microbiology Laboratory, Public Health Agency of Canada, Winnipeg, Canada. They’re Everywhere is a mixed-media sculpture with whimsical watercolor elements that highlight the ubiquity of bacteria, particularly foodborne pathogens, in our world and the food we eat. The organisms’ menacing expressions contrast with the innocence of a bowl of noodles, underscoring hidden threats in everyday meals.
They’re Everywhere by Shelley Peterson, A/Head STI Unit, National Microbiology Laboratory, Public Health Agency of Canada, Winnipeg, Canada. They’re Everywhere is a mixed-media sculpture with whimsical watercolor elements that highlight the ubiquity of bacteria, particularly foodborne pathogens, in our world and the food we eat. The organisms’ menacing expressions contrast with the innocence of a bowl of noodles, underscoring hidden threats in everyday meals.
The Bleak Future by Shruti Shemawat, Assistant professor, Pathology, Government medical College, Dausa, Jaipur Rajasthan, India. This miniature clay artwork portrays the disturbing reality of food adulteration worldwide. From chocolates and baby formula to meat and fruits, everyday foods are increasingly contaminated, posing a serious threat to human health. If this reflects our present, one cannot help but question the future we are shaping for our children. The artwork urges us to pause, reflect, and take responsibility – before we pass a legacy of neglect and harm on to the next generation.
The Bleak Future by Shruti Shemawat, Assistant professor, Pathology, Government medical College, Dausa, Jaipur Rajasthan, India. This miniature clay artwork portrays the disturbing reality of food adulteration worldwide. From chocolates and baby formula to meat and fruits, everyday foods are increasingly contaminated, posing a serious threat to human health. If this reflects our present, one cannot help but question the future we are shaping for our children. The artwork urges us to pause, reflect, and take responsibility – before we pass a legacy of neglect and harm on to the next generation.
Campbell’s Soup or Bacterial Broth? by Valentina Antonelli, Rome, Italy. The image depicts a pop art–style soup can inspired by Andy Warhol, surrounded by three hands – clean, gloved, and dirty. The dirty hand links to a microscopic view of bacteria, while a stain on the can suggests contamination. Highlighting the risk of cross-contamination, a central food safety concern, the piece draws on laboratory experience to show how everyday moments – such as preparing or sharing meals – can carry unseen microbial risks.
Campbell’s Soup or Bacterial Broth? by Valentina Antonelli, Rome, Italy. The image depicts a pop art–style soup can inspired by Andy Warhol, surrounded by three hands – clean, gloved, and dirty. The dirty hand links to a microscopic view of bacteria, while a stain on the can suggests contamination. Highlighting the risk of cross-contamination, a central food safety concern, the piece draws on laboratory experience to show how everyday moments – such as preparing or sharing meals – can carry unseen microbial risks.
MicroArt by Fusarium: The Beauty of Invasion by Zeynep Sena Gönen Göl, Medical Microbiology Resident and Research Assistant, Hacettepe University Faculty of Medicine, Department of Medical Microbiology, Ankara, Turkey. This image captures the delicate architecture of fungal hyphae in a human clinical sample, revealing unexpected harmony between pathology and art. What is usually seen as disease appears as an intricate, almost botanical form. The work suggests that even pathogens can display striking beauty under close observation, blurring the line between art and illness.
MicroArt by Fusarium: The Beauty of Invasion by Zeynep Sena Gönen Göl, Medical Microbiology Resident and Research Assistant, Hacettepe University Faculty of Medicine, Department of Medical Microbiology, Ankara, Turkey. This image captures the delicate architecture of fungal hyphae in a human clinical sample, revealing unexpected harmony between pathology and art. What is usually seen as disease appears as an intricate, almost botanical form. The work suggests that even pathogens can display striking beauty under close observation, blurring the line between art and illness.
Invisible Journey by Zibeyda Gambarova, Baku, Azerbaijan. This work traces the invisible journey of microorganisms on Sabouraud agar, from farms and animals to feed and soil – unseen, yet present. They then reach the plate, entering food meant to be safe, where lapses in handling or storage allow them to spread. The piece reminds us that interrupting this journey early prevents its consequences.
Invisible Journey by Zibeyda Gambarova, Baku, Azerbaijan. This work traces the invisible journey of microorganisms on Sabouraud agar, from farms and animals to feed and soil – unseen, yet present. They then reach the plate, entering food meant to be safe, where lapses in handling or storage allow them to spread. The piece reminds us that interrupting this journey early prevents its consequences.